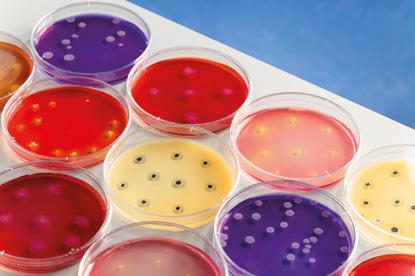

Funzionali Alimenti
SALUTE BENESSERE BELLEZZA
grandimolini.it




![]()
grandimolini.it




3
Unplugged
4
Diritto alimentare
Data di scadenza alterata. Le recenti posizioni della cassazione penale sulla frode in commercio (G. Andreis)
8 Aromi
A qualcuno piace piccante (C. Ghizzoni)
12 Igiene
Clostridium botulinum, un killer silenzioso nascosto nel cibo? (G. Comi)
18 Ristorazione
Modernizzare la tradizione in cucina, evoluzione o tradimento? (R. Carcangiu)
20 Functional trend
L’innovazione negli alimenti e nelle bevande funzionali
24
Salute e benessere
Favorire l’eliminazione di microplastiche - A tutta salute - Ripartire con il supporto della natura - Potassio e zinco riducono il rischio di depressione - Barbabietola per la pressione sanguigna
28 Nutrizione e fitness
Il gelato “sportivo” (R. Bianchi) - Idratazione in uno stick - Esercizi per non cadereAgitare prima di bere - Frutta e proteine
34 Alimentazione
I vermi commestibili della farina (A. Bongiovanni) -
Conosciamo a fondo l’EVOO (F. Orsini) - Estratti vegetali negli integratori alimentari e negli alimenti comuni. Parte 2 (L. Caricchio)
44 Free from Le fonti di fibra solubili e insolubili (R. Del Santo) - Linee guida sulle alternative vegetali alla carne - L’alternativa 100% vegetale
48 La golosità del senza Intollerante a chi?! (C. Capuano)
52 Ricette funzionali
Tofu con verdure e salsa al burro di arachidi e miso
54 Nuove proposte
Un frutto antico per una dolcezza moderna - Una pizza contemporanea con risultati da professionista - Aromi naturali da estrazione fisica
56 L’intervista
Le grandi potenzialità del fico d’India
59 Notizie dal mondo
Gli italiani puntano sull’alimentazione - Countdown per la prima di FIBO ArabiaFi Europe 2025 torna a Parigi per la 30ª edizione - Probios acquisisce la maggioranza di BMS Organic
62 Contaminazioni senza rete
64 Indirizzi aziende

Settembre 2025 anno 17 numero 55
3 Unplugged
4 Food law
8 Flavor
12 Hygiene
18 Food service
20 Functional trend
24 Health & wellness
28 Nutrition & fitness
34 Food
44 Free from
48 The gluttony of free from
52 Functional recipes
54 New suggestions
56 Interview
59 News
62 Limitless contaminations
64 Companies’ address

TRIMESTRALE - ISSN 2039-6155
September 2025 Year 17 Number 55
ASSOCIATO A:










I NOSTRI SITI
www.chiriottieditori.it www.foodtechvillage.com www.pasticceriainternazionale.it www.tuttogelato.it www.alimentifunzionali.it www.foodexecutive.com
Chiriotti Editori s.r.l. Viale Rimembranza 60 10064 Pinerolo - To - Italia Tel. 0121 393127 info@chiriottieditori.it www.chiriottieditori.it
Direttore Responsabile
Livia CHIRIOTTI livia@chiriottieditori.it
Direttore Editoriale
Alberto CHIRIOTTI alberto@chiriottieditori.it
Coordinatore Scientifico
Sebastiano PORRETTA
Redazione
Laura SBARATO, Rossella CONTATO Chiara MANCUSI, Matteo BARBONI
Segretaria di Redazione Elena FOLCO folco@chiriottieditori.it
Grafica
Anna BOSCOLO
Direttore Marketing
Monica PAGLIARDI pagliardi@chiriottieditori.it
Pubblicità
Luca RUSSO russo@chiriottieditori.it
Ufficio Traffico
Monica PRIMO primo@chiriottieditori.it
Amministrazione Giuseppe CHIRIOTTI
Abbonamenti
Marilù CIANFLOCCA abbonamenti@chiriottieditori.it
Resp. Trattamento Dati
Ottavio CHIRIOTTI
ABBONAMENTO
Alimenti Funzionali 4 fascicoli cartacei € 20,00
PER ABBONARSI
Telefonare allo 0121 378147 (servizio abbonamenti) o inviare una e-mail a: abbonamenti@chiriottieditori.it
La riproduzione, anche parziale, di articoli ed illustrazioni pubblicati sulla rivista è riservata e non può avvenire senza espressa autorizzazione scritta dell’Editore. I materiali originali inviati alla redazione non saranno restituiti, anche se non pubblicati. L’Editore non assume alcuna responsabilità per quanto riguarda eventuali errori contenuti negli articoli e/o per quanto espresso dagli Autori. Gli inserzionisti sono i soli responsabili di quanto pubblicato nelle loro pagine di pubblicità.
STAMPA: La Stamperia Pinerolese srls Pinerolo (To)
PROPRIETÀ: © 2025 Chiriotti Editori srl
AUTORIZZAZIONE: n. 21 del 09/09/2015 Registrazione Tribunale di Torino PERIODICITÀ: trimestrale - Spedizione A.P. L 27/02/2004 n. 46 art. 1
Prezzo una copia € 1,00 numeri arretrati € 10,00
This quarterly journal is happily published by Chiriotti Editori srl Viale Rimembranza, 60 10064 - Pinerolo (TO) - Italia Tel. +39 0121 39 31 27www.chiriottieditori.it info@chiriottieditori.it
1 year subscription Italy: € 20.00
Abroad: € 40.00

Dopo i recenti casi gravi di botulismo, vale la pena riprendere qualche chiarimento sul Clostridium Botulinum a beneficio dei lettori.
L’intossicazione da Clostridium Botulinum è una delle più temute e note malattie a trasmissione alimentare che può avere anche, come più volte purtroppo stiamo vedendo, esiti fatali. Inattivare o bloccare la germinazione delle spore di Clostridium Botulinum è la sola strategia per rendere sicure le conserve alimentari. Ma non sempre questo è possibile, soprattutto a livello casalingo. Negli alimenti definiti non acidi, ovvero con un pH >4,6 l’inattivazione delle spore può essere raggiunta solo con trattamenti termici di sterilizzazione a temperature non raggiungibili a livello domestico (>100°C). La sicurezza sanitaria nei confronti del Clostridium Botulinum può essere ottenuta acidificando gli alimenti a valori di pH ≤ 4,6. Tuttavia, questo valore così preciso non può essere determinato senza l’ausilio di uno strumento di laboratorio, il pHmetro
A livello casalingo è possibile solo, e con molta attenzione, preparare conserve di prodotti naturalmente acidi o che possano essere acidificati o ai quali
possa essere aggiunta un’adeguata quantità di sale o di zucchero.
Se si volessero preparare conserve di verdure sottolio, sarebbe necessario cuocere le verdure in una soluzione di acqua
proporzionato alla sua grandezza: per vasi da 350-400 g sono sufficienti 15-20 minuti
Il Ministero della Salute, insieme ad altri enti, ha pubblicato delle linee guida per fornire al consumatore indicazioni semplici e

e aceto in uguali proporzioni, scolarle, raffreddarle, asciugarle prima di trasferirle in un contenitore, riempiendo tutto lo spazio disponibile e ricoprendole interamente con olio. Il contenitore chiuso in modo ermetico dev’essere immerso completamente in una pentola e fatto bollire in modo continuo per un tempo
chiare che, se applicate correttamente, permettono di preparare alcune conserve casalinghe in tutta sicurezza.
Ricordo che questi e molti altri argomenti analoghi sono trattati, in modo molto semplice, nel podcast Il Gusto di Saperlo, disponibile gratuitamente su tutte le piattaforme.

Un’interessante sentenza della III Sezione Penale della Corte di Cassazione, emessa il 18 dicembre 2024 (n. 46542), ha come oggetto il reato di frode in commercio per alterazione della data di scadenza. Come sappiamo, il codice penale punisce chiunque consegni una cosa diversa da come è presentata; in sostanza, dunque, punisce penalmente l’operatore che riporti in etichetta (così come su altri supporti) indicazioni o dichiarazioni che non trovano riscontro nelle caratteristiche del prodotto. L’art. 515 c.p., più precisamente, prescrive che “Chiunque, nell’esercizio di una attività commerciale, ovvero in uno spaccio aperto al pubblico, consegna all’acquirente una cosa mobile per un’altra, ovvero una cosa mobile, per origine, provenienza, qualità o quantità, diversa da quella dichiarata o pattuita, è punito, qualora il fatto non costituisca un più grave delitto,
con la reclusione fino a due anni o con la multa fino a 2.065 euro”. Nel caso trattato davanti ai Giudici di Cassazione, presso i magazzini di

“Il prolungamento della shelf-life di un prodotto, laddove possibile, dev’essere studiato e supportato tecnicamente con prove adeguate, per attribuirgli una corretta durabilità e per poterla rivendicare in etichetta (è sempre opportuno condividere tali operazioni con la ACL)
un commerciante all’ingrosso erano state rinvenute derrate alimentari che riportavano una data di scadenza alterata. La durabilità attribuita ai prodotti in questione era stata modificata e “allungata”, facendo sì che, a quel punto, l’etichetta non corrispondesse più a quella loro caratteristica.
La giurisprudenza che si è consolidata negli anni in effetti riconosce il reato di frode in commercio nell’alterazione/modifica della data di scadenza degli alimenti, ma in questo caso, ciò che rende peculiare la sentenza di fine 2024 sta nel fatto che, secondo i Giudici, tale reato è commesso, nella forma di tentativo, anche qualora detti alimenti siano stoccati presso i magazzini aziendali (in una cella frigo) e non ancora esi-

“tati alla vendita. Questa circostanza emerge dalla massima della sentenza che riporta, in maniera succinta e chiara, che “Per integrare il reato di frode in commercio è sufficiente la detenzione dei prodotti alimentari con confezioni alterate in magazzino perché dimostra l’intenzione alla vendita”.
Il motivo per cui la Cassazione giunge a questa conclusione si comprende ripercorrendo i fatti.
Nel caso esaminato dai Giudici, l’imputato, legale rappresentante di un’azienda che si occupa di commercio all’ingrosso di alimenti e bevande, aveva conservato in una cella frigo del suo magazzino diverse confezioni di riso proveniente dall’Inghilterra; sulle confezioni erano riportate, da un lato, la data di scadenza inglese, quella cioè determinata dal produttore (exp. date…2016), dall’altro, una diversa data espressa tramite il TMC in lingua italiana, recante “Consumarsi preferibilmente entro il …… 2018”.
Durante l’istruttoria è risultato evidente come l’anomala compresenza delle due date, l’una in inglese e l’altra in italiano, fosse frutto di un’aggiunta operata dal commerciante all’ingrosso e come tale aggiunta rappresentasse chiaramente l’intento di prolungare la vita commerciale del prodotto al fine della vendita ai consumatori finali.
Al di là degli aspetti più tecnici che non risulta siano stati trattati (i Giudici non scendono nel dettaglio della differenza fra data di scadenza e TMC, ad esempio, né su come
sia stata determinata la diversa shelf-life del riso), sono piuttosto aspetti di carattere logico che supportano le motivazioni della sentenza. L’imputato, infatti, aveva sostenuto nelle sue difese che la presenza della data di scadenza inglese escludesse ogni profilo d’ingannevolezza, perché metteva comunque il consumatore nella condizione di conoscere la durabilità effettiva del prodotto. Secondo i Giudici, tale circostanza non poteva essere condivisa, in quanto era per loro evidente che la collocazione dell’attività (il riso era conservato a temperatura controllata in una cella frigo, quindi in una struttura dedicata al mantenimento di merci “vive”, non destinate alla distruzione o allo smaltimento) e la collocazione in Italia “rendeva del tutto verosimile che il prodotto sarebbe stato offerto in vendita proprio nel Paese e che dunque l’idoneità all’inganno della falsa indicazione non poteva esser negata”. A nulla è valsa la circostanza che la merce fosse ancora detenuta presso l’ingrosso e non già posta sugli scaffali per la vendita al consumatore. Come anticipato, una precedente giurisprudenza riteneva che la detenzione della merce presso i magazzini aziendali non raffigurasse il tentativo di frode in commer-

cio, poiché, in sostanza, non ancora capace d’ingannare l’acquirente; con questa sentenza la Cassazione chiarisce invece che “la affermazione di responsabilità non si fonda sulla mera presenza della merce all’interno del deposito, ma su un complesso di elementi oggettivi e distinti che, letti contestualmente senza alcun vizio logico, hanno adeguatamente giustificato la pronuncia di condanna”. Complesso di elementi oggettivi e distinti, costituito, come detto, dalla collocazione della attività e della
Anche la detenzione presso i magazzini di merce destinata alla vendita al consumatore finale e non ad altri canali, come la distruzione, può già raffigurare la fattispecie penale nella forma del tentativo
merce nella cella frigo di un magazzino in Italia.
Si è dunque arrivati alla condanna dell’imputato, riconosciuto responsabile della tentata frode in commercio, stabilendo così un precedente che, riteniamo, vada attentamente considerato da parte degli operatori. Se da un lato, infatti, l’eventuale prolungamento della shelf-life di un prodotto, laddove possibile, dev’essere studiato e supportato tecnicamente con prove adeguate, intanto per attribuirgli una corretta durabilità, ma poi per poterla rivendicare in etichetta (per esperienza, aggiungiamo, che è sempre opportuno condividere tali operazioni con la ACL), dall’altro, va tenuto presente che anche la detenzione presso i magazzini di merce destinata alla vendita al consumatore finale e non ad altri canali, come la distruzione, può già raffigurare la fattispecie penale nella forma del tentativo.







Le spezie piccanti, aggiunte nei nostri piatti in quantità più o meno generose, sono il condimento più utilizzato nelle cucine del pianeta

Aqualcuno piace caldo” è il titolo di una celebre produzione cinematografica hollywoodiana di fine anni Cinquanta, interpretato da un cast stellare. In quel contesto, il termine “caldo” si riferisce allo stile jazzistico, ma la stessa frase può esprimere anche un altro significato ed essere tradotta dall’inglese con “A qualcuno piace piccante”. Ed è proprio di questa peculiare sensazione gustativa che ci occupiamo: una sensazione più o meno potente di calore, di bruciore formicolante in bocca, sperimentata nel consumo di alimenti speziati. Per una vasta parte di consumatori costituisce un’attrazione irresistibile, tanto da creare, in alcuni casi, una vera dipendenza. “Una questione di gusto” si direbbe, come risultato di una sensazione/emozione, in cui dolore e piacere si mescolano e il gusto è qualcosa di sfuggente, soggettivo, un regno in cui si incrociano biologia, cultura ed “
esperienze personali. Ad oggi, le spezie piccanti, aggiunte nei nostri piatti in quantità più o meno generose, sono il condimento più utilizzato nelle cucine del pianeta.
Da un punto di vista storico, la più significativa tra le spezie è senza dubbio il pepe; si stima che per secoli abbia costituito oltre il 30% del valore dell’intero commercio delle spezie. Pianta del genere Piper originaria dell’India, era coltivato fin nella preistoria, con molta probabilità già nel 3000 a.C. Una curiosa testimonianza di un suo remoto impiego risale al 1200 a.C., periodo di datazione della morte di Ramsete II: gli archeologi hanno rinvenuto alcuni grani della preziosa spezia nella narice della mummia del faraone.
La leggenda narra che i suoi grani trasportati per distanze enormi, attraverso percorsi impervi e avventurosi, vennero introdotti in Grecia da
Alessandro Magno, denominati come péperi per essere conosciuti poi nel mondo latino con il termine di piper Nelle civiltà elleniche era conosciuto e ampiamente impiegato più per le sue presunte proprietà medicamentose e come antidoto ai veleni, piuttosto che per le proprietà aromatizzanti. Fu nella Roma imperiale che si affermò come preziosa materia prima gastronomica, capace di apportare la seducente sensazione di piccantezza. In epoca imperiale la varietà a grani lunghi Piper longum era la spezia più diffusa e richiesta, tanto da essere considerata come “la regina delle spezie”. Solo a partire dal millennio cominciò a diffondersi nel continente europeo il Piper nigrum a grani tondi bianchi e neri. Come tutte le spezie di origine esotica, il pepe è stato materiale prezioso, riservato alle classi sociali più elevate e impiegato come una materia prima per le preparazioni gastronomiche e come mezzo di affermazione e ostentazione del proprio prestigio sociale.
Al suo caratteristico profumo contribuiscono vari composti di natura terpenica che sono i maggiori componenti dell’olio essenziale, frazione volatile ottenibile dalla distillazione in corrente di vapore dei semi; mentre il suo sapore pungente è dato dall’alcaloide piperina presente nella buccia del frutto e negli strati superficiali del seme, in concentrazione variabile tra il 3 e il 9%, e ottenibile dai semi mediante processo di macerazione ed estrazione con solventi organici. Interessante sottolineare che una semplice modificazione della sua conformazione provoca la perdita della sua proprietà di piccantezza. È ciò che accade al pepe macinato sottoposto a una prolungata esposizione alla luce solare; la radiazione ultravioletta induce un cambio strutturale della molecola che genera l’isomero insapore isochavicina
Altra sapida e appetita spezia è lo zenzero, Zingiber officinale, originaria dell’area indomalese e lì coltivato fin dai tempi più remoti; appartiene alla famiglia delle Zingiberaceae che comprende un numero di circa 1.400 specie diverse, tra cui le conosciute curcuma e cardamomo. Impropriamente considerato come radice, è in realtà un rizoma, vale a dire parte del fusto o gambo della pianta che ha uno sviluppo per lo più sotterraneo. La spezia vanta una tradizione di coltivazione millennaria, un esteso impiego nelle preparazioni di cucina indiana, per conferire sapore a piatti di riso insipidi e ingrediente in un elevato numero di formulazioni medicinali. È tra le spezie di origine esotica la più semplice da trapiantare e coltivare, ma nonostante ciò per secoli, prima dell’avvento della tecnologia della refrigerazione, nessun europeo ha avuto l’occasione di consumarlo fresco: arrivava ai mercati dopo lunghi viaggi in carovana, in forma essiccata, sia in polvere che intera. Il caratteristico aroma del rizoma fresco risulta composto da una miscela di note fresche, verdi, citriche, con un lieve sottofondo terroso, mentre per la versione essiccata il profilo aromatico, espressione di una differente composizione della frazione volatile, si arricchisce di note legnose, calde con una decisa prevalenza di sentore terroso.
Come per il pepe, anche il profumo dello zenzero risulta essere generato da molecole di natura terpenica; il più abbondante tra queste è un composto caratteristico della specie, da cui prende il nome: zingiberene. Il principio attivo, presente in discrete quantità nello zenzero fresco e responsabile della sensazione pungente, è il (6)-gingerolo e relativi isomeri, composti riscontrabili in varie concentrazioni

La generazione della sensazione del piccante è del tutto estranea all’attivazione delle cellule nervose del gusto e dell’olfatto
“ “
L’essere umano non nasce con una spiccata predilezione per i gusti incisivi e spiacevoli, ma nel corso del suo sviluppo le avversioni possono tramutarsi in fonti di piacere
in tutti i membri della famiglia delle Zingiberaceae, non presenti nella frazione volatile, ma isolabili dal rizoma per estrazione con solventi organici. La cottura dello zenzero produce una sensibile riduzione della sensazione di piccantezza dovuta alla degradazione, indotta termicamente, della molecola del gingerolo; reazione che porta alla generazione dello zingerone. Diversamente, il processo di essiccazione produce un’apprezzabile intensificazione della pungenza, in quanto il gingerolo, subendo una reazione di disidratazione, si trasforma in una miscela di isomeri chiamati shoagoli e dotati di un maggiore potere di piccantezza.
Un esemplare appartenente alla famiglia delle Zingiberaceae, erroneamente considerato come un “sosia” del pepe, è costituito dal Aframomum melegueta, conosciuto in epoche antiche come il pepe africano e largamente utilizzato fino al secolo XVI, anche come succedaneo della più nobile spezia di origine indiana. Oggi, caduto il suo momento di favore, la commercializzazione della spezia, nota anche come “grani del paradiso”, è confinata nei negozi specializzati e trova impiego in preparazioni di elevata gourmetizzazione. Interessante sottolineare come la sua caratteristica fragranza sia simile a quella del cardamomo, mentre la sua proprietà di pungenza è generata da una molecola, conosciuta come (6)-paradolo, avente una struttura molecolare simile al (6)-shoagolo
peperoncino, la spezia dei poveri
Veniamo ora alla regina delle spezie piccanti, il peperoncino. Giunto a noi dopo la scoperta del Nuovo Mondo, fu tra i primi vegetali importati in Spagna
e ad essere diffuso nei territori controllati dalla corona spagnola. La spezia veniva impiegata dalle popolazioni amerindie già da qualche millennio come insaporitore dei loro piatti a base di mais. A differenza delle spezie originarie delle Indie orientali, il peperoncino si rivelò un clamoroso fiasco commerciale; infatti, non generò gli attesi guadagni per i mercanti spagnoli che, con questo nuovo frutto avente un potere piccante decisamente intenso, speravano di minare la predominante posizione del pepe. In principio fu guardato con sospetto, ma lentamente e in modo progressivo cominciò a diffondersi in tutto il territorio europeo, in virtù della sua facilità di coltivazione che consentiva abbondanti crescite in qualsiasi terreno, rendendolo economico, accessibile a tutti, al punto di essere chiamata “la spezia dei poveri”. La pianta esportata poi dai mercanti portoghesi nel continente africano e asiatico, lì conobbe un clamoroso successo, dato che le preferenze di gusto di quelle popolazioni si sono da sempre espresse per piatti dai sapori decisi e intensi. Con il nome di peperoncino s’indica un’ampia varietà di piante del genere Capsicum e nello specifico della annum specie sono noti un elevato numero di differenti cultivar, come il pepe di Cayenna, il mitico Habanero e il popolare e apprezzato Chili, solo per citarne alcuni.
La pianta del peperoncino non possiede un sistema di biosintesi volto a produrre discrete quantità di sostanze odorose, quanto piuttosto orientato alla generazione di molecole non volatili e in particolar modo di capsaicina e relativi isomeri (capsacinoidi), sostanze con il più elevato potere di piccantezza. La molecola, scoperta quasi contemporaneamente alla piperina, è stata isolata in Germania da un estratto concentrato, ottenuto dalla macerazione dei frutti di peperoncino con solventi organici.
Proprio a partire da un estratto di peperoncini essiccati, il chimico statunitense Wilbur Lincoln Scoville (1865-1942) un secolo fa mise a punto un metodo per valutare su base sensoriale il potere di piccantezza della capsaicina. Il test, tuttora utilizzato, prevede delle diluizioni progressive in soluzione zuccherina di un estratto di peperoncini a peso noto, fino all’assenza della percezione di piccantezza, rilevata da un gruppo di giudici addestrati. Il grado della sensazione di pungenza viene elaborato in relazione al numero di diluizioni: per esempio, a un campione valutato 100.000 SHU (Scoville Heat Units) è stato applicato un fattore di diluizione di 1 (una) parte di estratto in 100.000 parti di soluzione per neutralizzare la sensazione di piccantezza. Sulla base del valore di SHU determinato, al campione può essere calcolato un corrispondente contenuto in capsaicina pari allo 0,625%, in quanto nella scala Scoville alla capsaicina pura è stato assegnato un valore di 16.000.000 SHU. Per quanto riguarda le molecole che abbiamo citato in questo articolo, il metodo Scoville assegna alla piperina un valore di 150.000 SHU, poco inferiore ai 160.000 dello shogaolo, ma decisamente maggiore rispetto ai 60.000 del (6)-gingerolo e suoi isomeri, zingerone a 37500 SHU.
Come si genera la sensazione del piccante
A completamento di questa breve rassegna sulle sostanze responsabili di vivaci e intense percezioni che possono essere di dolore o di piacere, in relazione alle soggettive predilezioni, diamo un rapido cenno alle modalità di generazione di queste sensazioni nel nostro “sistema del gusto”.
La generazione della sensazione del piccante è del tutto estranea all’attivazione delle cellule nervose del gusto e dell’olfatto. È tecnicamente definita come chemestetica, dove il termine chemestesi è utilizzato per definire la sensibilità nei confronti di sostanze in grado di generare uno stimolo paragonabile a una sensazione termica o meccanica. Le sostanze citate hanno la proprietà di stimolare chimicamente i recettori delle fibre del nervo trigemino a livello della mucosa del naso e del cavo orofaringeo, generando una sensazione di calore bruciante più o meno intensa, fino ad arrivare in alcuni casi a sensazioni di soffocamento. Come uno stimolo irritante, un’esperienza di dolore possa essere convertita da noi umani in una fonte di piacere è oggetto di studi in varie discipline scientifiche, ma questo fenomeno si verifica soprattutto in cucina, dove oltre un terzo della popolazione mondiale consuma copiose quantità di spezie piccanti per rendere più appetitosi i cibi. L’apprezzamento della sensazione del piccante ha in sé elementi complessi, l’essere umano non nasce con una spiccata predilezione per i gusti incisivi e in qualche modo spiacevoli, ma nel corso del suo sviluppo le avversioni infantili possono tramutarsi in fonti di piacere, ricercando nel cibo quelle brucianti sensazioni che ne esaltano il sapore. Le nostre predilezioni sono determinate da cause di natura diversa, dove s’intrecciano e combinano fattori culturali, sociali e, in particolare, psicologici e soggettivi, i quali fanno sì che siano il sistema nervoso centrale e la sua attività a modellare i criteri di valutazione e di piacere sensoriale.

Esiste realmente un rischio nelle conserve, ma questo viene facilmente eliminato attraverso un severo controllo del processo produttivo

Tra i microrganismi patogeni d’interesse alimentare troviamo Clostridium botulinum (Cb), responsabile del botulismo, malattia neuro-paralitica, evidenziato per la prima volta nel 1897 da Emile van Ermengem, in seguito a un focolaio alimentare verificatosi nella cittadina belga di Ellezelles, in occasione di un funerale. Il nome deriva dal latino botulus (salsiccia), perché tale batterio è stato inizialmente associato al consumo di salsicce preparate in casa. Tuttavia, almeno in Italia, la maggior parte dei casi di botulismo è legata al consumo di prodotti sottolio di origine vegetale.

La malattia può essere classificata in sei forme: alimentare, dovuta alla presenza della tossina (si parla d’intossicazione) nell’alimento; da ferita, dovuta allo sviluppo di Cb che si sviluppa nei tessuti, dopo esservi penetrato attraverso ferite; infantile, causato dall’ingestione del batterio e successiva colonizzazione dell’intestino di lattanti (< 1 anno); da colonizzazione intestinale dell’adulto, patologia con le stesse modalità del botulismo infantile e colpisce la popolazione (> 1 anno) che non ha un efficace attività microbica intestinale; iatrogeno, causata dall’impiego errato delle tossine a scopo terapeutico o cosmetico; da inalazione, dovuta al rilascio deliberato o accidentale nell’aria delle tossine botuliniche.
In sintesi: Cb è sporigeno, per cui sopravvive nell’ambiente e anche alla cottura degli alimenti. È anaerobo, e quindi cresce solo in assenza di ossigeno, non ha particolari esigenze

nutrizionali e potenzialmente può sviluppare in materie prime e alimenti finiti. È presente nel suolo, nei sedimenti marini e lacuali, nel pulviscolo atmosferico e da lì contamina vegetali e animali, e ogni materia prima alimentare. Se presente negli alimenti, soprattutto nelle conserve, la spora germina e si trasforma in cellula e, in seguito al suo sviluppo, produce la tossina che, se ingerita dall’uomo, causa un’intossicazione, spesso mortale. La tossina è una proteina complessa, che è attivata da enzimi (proteasi) prodotti dallo stesso microrganismo o da enzimi intestinali, ed è distrutta dal calore. Purtroppo, gli alimenti responsabili di tale intossicazione non sono ulteriormente trattati al calore prima di essere consumati (es. vegetali sottolio, carni bovine o ittiche in scatola). Sono conosciute circa nove diverse (varianti) tossine botuliniche denominate con le lettere dell’alfabeto (A-H, X). Tuttavia, le tossine che rivestono importanza nella patologia umana sono quasi esclusivamente quelle di tipo A, B, E e, più raramente, F. Le tossine botuliniche sono tra le molecole più tossiche per l’uomo. Si stima che 1 g di tossina pura possa provocare la morte di 14.000 persone se assunta per ingestione, 1.250.000 persone per inalazione e 83.000.000 per iniezione. Proprio a causa della loro altissima letalità, possono essere utilizzate come armi biologiche e agenti del bioterrorismo. La Tab. 1 riporta le principali caratteristiche del Cb e i sintomi della patologia. La sintomatologia caratteristica del botulismo ha una progressione simmetrica (interessa entrambi gli emisferi del corpo) e discendente (dalla testa al collo, al torace, fino alla paralisi degli arti) e si manifesta con una paralisi flaccida, che è quasi sempre fatale. Tuttavia, se diagnosticata in tempo, il colpito può sopravvivere
Il
nome deriva dal latino botulus (salsiccia), perché tale batterio è stato inizialmente associato al consumo di salsicce preparate in casa
“ ”
Tabella 1 - Principali caratteristiche di Cb e i sintomi della patologia. Colpisce tutte le età
I sintomi compaiono da poche ore (5-6) a 15 giorni – In Italia entro le 24-72 ore dall’ingestione
Sintomi specifici
• annebbiamento e sdoppiamento della vista (diplopia)
• dilatazione delle pupille (midriasi bilaterale)
• difficoltà a mantenere aperte le palpebre (ptosi)
• difficoltà nell’articolazione della parola (disartria)
• difficoltà di deglutizione
• secchezza della bocca e delle fauci (xerostomia)
• stipsi
• ritenzione urinaria
Sintomi gravi con esito spesso fatale insufficienza respiratoria, per blocco della conduzione nervosa ai muscoli responsabili della respirazione (paralisi flaccida)
Terapia per la guarigione (obbligo ricovero ospedaliero)
• ventilazione assistita
• decontaminazione intestinale con carbone attivo, che assorbe la tossina.
• nutrizione parenterale
• somministrazione di un siero iperimmune (da Ministero della Salute)
e il recupero può durare da qualche settimana a diversi mesi.
Il Cb cresce in un ambiente strettamente anaerobo, in bassa acidità (pH > 4,5) e concentrazione di sale (< 3,5%), in alta umidità, e a temperatura ambiente, anche se alcuni
biotipi di Cb (tipo E) possono crescere a 4°C, seppur in tempi lunghi, e in presenza di consistenti fonti di proteine e aminoacidi.
Tutte le conserve a base vegetale o animale. In particolare, i vegetali sottolio, i pesci in scatola (tonno, sardine), alcuni salumi e le carni bovine in scatola. Le conserve sono alimenti che subiscono trattamenti (sterilizzazione, acidificazione, salagione, salagione e maturazione, aggiunta di additivi, nitriti), che permettono la conservazione anche a temperatura ambiente. È ampiamente assodato che tutti casi di botulismo in Italia, e nel mondo, sono dovuti a grossi errori nella produzione delle conserve. Infatti, mentre la presenza di Cb non può essere sempre evitata, essendo ubiquitario, può essere evitato il suo sviluppo. Il Cb è un microrganismo facilmente controllabile, qualora si applichi severamente ogni fattore che favorisca la sua inattivazione o ne impedisca lo sviluppo.

La Tab. 2 riporta gli alimenti a rischio e i metodi per evitare la presenza di Cb, il suo sviluppo, la produzione di tossine e l’intossicazione.
Dalla tabella emerge che le conserve, le semi-conserve non acide o che non hanno subito trattamenti di acidificazione/fermentazione o sterilizzazione adeguati sono a rischio. Le conserve di produzione industriale generalmente non sono pericolose, perché la tecnologia di produzione è standardizzata e controllata, consentendo di impedire lo sviluppo, la tossinogenesi o l’eliminazione delle spore dei clostridi produttori di tossine botuliniche.
Le conserve effettuate in ambito domestico sono più pericolose, perché spesso vengono ottenute senza un reale controllo e realizzate seguendo ricette tramandate nel tempo. In Italia, i vegetali sott’olio di produzione domestica sono i maggiori responsabili dei casi di botulismo. La crescita di Cb avviene a causa di un’insufficiente acidificazione. L’errore è l’insufficiente tempo di bollitura del prodotto in acqua/aceto/sale, per cui il pH (il grado di acidità finale) non è inferiore a 4,5 unità.
Lavare il vegetale, per poi usarlo integro, affettato o cubettato, salato e messo in una soluzione acqua/aceto (1/1) in ebollizione. Portare nuovamente a ebollizione la soluzione e contare i minuti, come da tradizione o da manuale. Quindi, recuperare il prodotto, raffreddarlo e asciugarlo. Metterlo nei vasetti, sterilizzati per bollitura precedentemente, aggiungere l’olio, tenendo presente di non lasciare aria all’interno tra olio e prodotto; aria che potrebbe creare ossidazioni o sviluppo di muffe.
Pastorizzare i vasetti, attraverso bollitura in acqua, per favorire il sottovuoto e inattivare i lieviti, che potrebbero sviluppare sul vegetale, pur essendo acido e alterarlo (producono anidride carbonica, che fa gonfiare la confezione). Con la bollitura iniziale in acqua/aceto/sale, la polpa del vegetale viene acidificata (pH < 4,5) e ciò impedisce lo sviluppo di batteri e soprattutto di Cb che, in queste condizioni, potrebbe crescere a causa dell’ambiente anaerobo prodotto dall’olio e dalla temperatura di conservazione (ambiente).
I tempi di bollitura del vegetale sono tramandati dalla cultura contadina o presi da manuali di cucina. Per la corretta preparazione delle conserve alimentari in ambito domestico, si consiglia di consultare le linee guida elaborate dal Centro Nazionale di Riferimento per il Botulismo dell’ISS, in collaborazione con il Ministero del-
Tabella 2 - Alimenti a rischio e metodi per evitare presenza, sviluppo, produzione di tossine e intossicazione.
Alimento
Vegetali sottolio
Vegetali fermentati (es. olive da tavola)
Carni in scatola
Tonno in scatola
Pesci in scatola
Pesci e vegetali salati
Salmone affumicato
Salame/ Salumi crudi
Salumi cotti
Rimedio
Acidificazione del vegetale fino a pH < 4,5
Raggiungimento valore di pH < 4,5 tramite fermentazione di batteri lattici
Nitrito (min 80 mg/kg carne) –Sterilizzazione (121°C per 30 minuti minimo)
Sterilizzazione
Sterilizzazione
Concentrazione sale (min 7-10%)
Concentrazione sale nella fase acquosa della carne (Water Phase Salt) > 3,5%Conservazione a 4°C max.
Crescita/
Uccisione spore Cb
Nessuna crescita
Nessuna crescita
Nessuna crescita e Uccisione spore
Uccisione spore
Uccisione spore
Nessuna crescita
Nessuna crescita
Nitrito min 80 mg/kg – Disidratazione/ Maturazione Nessuna crescita
Nitrito min 80 mg/kg – Refrigerazione Nessuna crescita
Prosciutto crudo No nitrito – Sale, Disidratazione/ Maturazione Nessuna crescita
Alimenti in genere Presenza di ossigeno Nessuna crescita
Alimenti in sottovuoto o in atmosfera protettiva priva di ossigeno
Conservazione a 4°C – self life max. 1 mese Nessuna crescita

la Salute, l’Università degli Studi di Teramo e il Centro Antiveleni di Pavia. I sottoli industriali non dovrebbero creare problemi di botulismo, perché il grado di acidificazione è misurato attraverso un pHmetro che, a livello familiare non abbiamo, per cui si ha la certezza che il pH sia sempre inferiore a 4,5.
Recentemente sono state ricoverate diverse persone e altresì si sono registrate alcune vittime: ciò ha indotto il sequestro su tutto il territorio nazionale di alcuni prodotti alimentari. Entrambe le vittime e i ricoverati avrebbero iniziato a sentirsi male dopo avere mangiato cibo da track food o nell’ambito di eventi estivi in piazza. A seguito di queste intossicazioni, il Dipartimento della prevenzione, della ricerca e delle emergenze sanitarie del Ministero della Salute ha immediatamente attivato tutti i protocolli sanitari. Il sistema di intervento ha reagito prontamente e ciò ha garantito ai pazienti l’accesso tempestivo ai sieri antitossina botulinica salvavita, eliminando il pericolo di altre morti. La rapidità dell’intervento è stata possibile grazie alla rete capillare della Scorta Strategica Nazionale Antidoti e Farmaci (SNAF) e alla collaborazione sinergica di tutti gli enti coinvolti. L’alimento scatenante è stato individuato in diverse conserve denominate “friarielli alla napoletana” e “cime di rapa”, prodotte a livello industriale e commercializzate ad uso ristorazione o in supermercati. Infatti, si tratta prevalentemente di confezioni da 1 kg. Sono in corso ulteriori indagini, ma si può ipotizzare che la crescita di Cb in queste conserve sia dovuta a un’insufficiente acidificazione (pH > 4,5).
Inoltre, il Ministero della Salute ha pubblicato la Nota n. 0034260 (2025) per prevenire il botulismo alimentare, in particolare riguardo a zuppe, conserve vegetali, verdure sottolio, preparazioni sottovuoto e polpa di avocado. Il documento fornisce indicazioni operative su come preparare e conservare gli alimenti in modo sicuro, invitando a prestare attenzione a contenitori gonfi o alterati e a seguire le indicazioni per una corretta cottura, soprattutto per gli alimenti a rischio. In particolare, il protocollo suggerisce (impone): la cottura completa o la bollitura degli alimenti quali metodi efficaci per distruggere le spore di Cb e le tossine. L’osservazione del contenitore: non consumare cibi da barattoli o confezioni gonfie o che presentano coperchi sollevati. La presenza di segni di alterazione: evitare alimenti che mostrano muffe, funghi o lieviti sulla superficie, in quanto segno di contaminazione. La conservazione corretta: seguire scrupolosamente le indicazioni per la conservazione e la preparazione degli alimenti, specie quelli casalinghi e a rischio. Inoltre, bisogna tenere presente che: la cottura/bollitura distrugge la tossina, ma non distrugge le spore, che sopravvivono e possono poi germinare producendo la tossina; lo sviluppo di tale batterio non sempre produce un’alterazione o un gonfiore della confezione (raro); la conservazione anche in frigorifero non sempre blocca lo sviluppo di Clostridium botulinum, perché in questa specie troviamo biotipi che crescono, seppur in tempi lunghi, anche a 4°C (biotipo E).
Il Ministero della Salute e l’Istituto Superiore della Sanità dovrebbero promuovere maggiormente l’obbligo d’istruire il personale che produce tali conserve e incrementare il controllo da parte del servizio pubblico nelle aziende conserviere, soprattutto se la materia prima è costituita da verdure.

Il contesto
Nel corso degli anni, MICRO ha sviluppato un terreno di coltura proprietario e una tecnica microbiologica unica che permette di contare diverse specie batteriche su una singola piastra, ottimizzando tempi e costi di analisi.
La sfida
Nonostante l’efficacia della metodologia, il conteggio manuale rimane un processo dispendioso in termini di tempo e soggetto a variabilità umana. Con l’evoluzione dell’Intelligenza Artificiale e delle tecnologie di visione artificiale, MICRO ha intravisto la possibilità di rivoluzionare ulteriormente il proprio approccio, aumentando velocità, precisione e standardizzazione dei risultati.
Il progetto IA
MICRO ha avviato un programma di ricerca e sviluppo all’avanguardia per creare un sistema integrato capace di identificare e contare in modo automatico diverse specie batteriche a partire da immagini di piastre di coltura. Il progetto si sviluppa in partnership con:
• Dynius – responsabile dello sviluppo del modello di visione artificiale basato su semantic segmentation e machine learning per riconoscere le colonie batteriche.
• Kaboom – responsabile dello sviluppo dell’applicazione web e test finale della soluzione integrata, garantendo usabilità e affidabilità sul campo.

• Benefici attesi
Pubbliredazionale
• Riduzione dei tempi di analisi grazie all’automazione del conteggio.
• Maggiore accuratezza e riduzione degli errori umani.
• Scalabilità del processo per volumi elevati di campioni.
• Standardizzazione dei risultati tra operatori e laboratori.
Visione futura
L’obiettivo di MICRO è rendere questa tecnologia uno standard per la microbiologia moderna , aprendo la strada a nuove applicazioni in ambito nutraceutico, alimentare e cosmesi.
www.micro-bio.it/

La tradizione è sacra. O almeno, così ci è stato sempre detto. Ma se provassimo a smontare questo dogma? È davvero un’eresia adattarla ai tempi moderni o siamo prigionieri di un’illusione romantica che ci àncora al passato mentre il mondo evolve?

Chi difende l’immobilità della tradizione spesso dimentica una verità essenziale: tutto ciò che oggi consideriamo tradizione un tempo era innovazione. La pizza? Un’evoluzione della cucina povera. Il design italiano? Frutto di sperimentazioni audaci. Perfino le festività popolari si sono trasformate nei secoli, adattandosi ai mutamenti sociali ed economici. Dunque, perché ogni cambiamento viene visto come un tradimento?
La nostalgia: è un’arma a doppio taglio
Siamo ossessionati dal mito dell’autenticità. Qualsiasi tentativo di innovare viene bollato come “snaturamento” o, peggio ancora, “mercificazione”. Ma se nessuno avesse mai


osato rompere gli schemi, saremmo ancora a mangiare solo cibi crudi nelle caverne. Evolversi è naturale. Il vero rischio? Rimanere immobili. La nostalgia può dare valore alle radici, ma può anche trasformarsi in un freno alla crescita. La cucina è artigianato esattamente come altri mestieri tradizionali che stanno scomparendo non per mancanza d’interesse, ma perché non si sono adattati alle nuove modalità di produzione e distribuzione. Eppure, chi ha saputo digitalizzare la vendita, raccontarsi sui social e innovare i materiali non ha perso autenticità, ma ha garantito il futuro proprio e dell’azienda.
Non basta tramandare usanze per puro senso di continuità: bisogna renderle vive, attrattive, competitive. Moda, design, gastronomia e tutto ciò che oggi chiamiamo tradizione, un tempo era una novità audace. Perché conservare un passato che non dialoga con il presente?
Rinnovare senza perdere l’anima
Modernizzare non significa tradire, raccontare la tradizione con un linguaggio contemporaneo, render-
la desiderabile anche per chi non l’ha vissuta. Tecnologie immersive, marketing digitale e rebranding intelligente sono strumenti che possono far rivivere ciò che rischia di diventare solo un reperto museale.
La vera sfida è mantenere un filo conduttore tra passato e presente, senza cadere nella riproduzione sterile. Meglio una tradizione viva, che si evolva e affascini nuove generazioni, piuttosto che una tradizione “pura”, destinata a scomparire perché non più funzionale.
Se pensiamo alle eccellenze italiane, come cucina, moda, artigianato, ciò che celebriamo oggi è il risultato di una continua trasformazione. Il segreto? Bilanciare il rispetto delle radici con la capacità di evolversi. Chi resta indietro per paura del cambiamento rischia di essere dimenticato.
Prendiamo ad esempio il settore vinicolo: un tempo il vino veniva prodotto seguendo tecniche tramandate da generazioni, senza deviazioni. Oggi, grazie alla ricerca e alle innovazioni enologiche, le cantine valorizzano i vitigni storici migliorandone la qualità e rendendoli competitivi a livello internazionale. Questo non è tradimento, ma evoluzione intelligente.
La nostalgia può dare valore alle radici, ma può anche trasformarsi in un freno alla crescita
L’innovazione nel settore di alimenti e bevande funzionali continua a ruotare attorno alla salute intestinale, all’aumento di energia e all’idratazione., Mintel esplora le tendenze globali.
Alla ricerca di opzioni salutari convenienti
Sebbene mangiare sano sia una priorità per i consumatori, la convenienza è altresì un problema per molti. In Germania il 61% dei consumatori che descrive la propria forma fisica come poco sana afferma che l’aumento del costo della vita ha reso meno accessibile uno stile di vita sano. Ecco perché molti stanno ora ricorrendo a
diverse strategie di risparmio, come l’acquisto di prodotti private label più convenienti.
Secondo Mintel, la quota di lanci di alimenti e bevande funzionali con marchio privato in Europa ha registrato un piccolo ma notevole aumento nell’anno fino ad agosto 2024. I settori di maggiore attività comprendono le bevande calde, il pesce lavorato, la carne e i suoi sostituti e i cereali per la colazione. La catena di supermercati britannica Asda ha lanciato “The Health Menu”, una gamma di oltre 40 prodotti alimentari approvati da nutrizionisti, tutti a partire da 75 centesimi, che comprende piatti pronti, snack e zuppe in scatola, con l’obiettivo di permettere di mangiare sano senza
Le novità più interessanti a livello internazionale nel segmento “functional”, oltre a un’analisi critica di quelle più attraenti in funzione dei trend e degli sviluppi dei mercati di riferimento. Un valore aggiunto per chi è coinvolto nello sviluppo dei prodotti. La rubrica è frutto di una collaborazione esclusiva tra “Alimenti Funzionali” e Mintel gnpd (global new products database), la più importante agenzia-osservatorio nel mercato mondiale dei prodotti di consumo.

Nella gamma “The Health Menu” di Asda ci sono anche i fagioli misti affumicati al barbecue.
spendere una fortuna. Ogni prodotto è chiaramente etichettato con specifiche funzioni salutari, che vanno dagli integratori energetici alla salute intestinale, fino alla salute della pelle.
Il ritmo frenetico della vita quotidiana, il crescente utilizzo della tecnologia e le continue crisi globali stanno causando affaticamento mentale e fisico. Sempre nel Regno Unito, l’80% degli adulti soffre di stress con difficoltà a dormire e mancanza di energia, presumibilmente i principali effetti, il che suggerisce opportunità d’innovare con prodotti calmanti e di reintegro energetico, anche in categorie alternative. Un esempio è quella dello yogurt, considerando che le proteine sono fonte di energia ampiamente riconosciuta (in Germania, il 24% di chi lo acquista ritiene che l’elevato contenuto proteico sia una caratteristica importante).
Per un invecchiamento sano
La regione Asia-Pacifico sta vivendo un significativo cambiamento demografico dovuto all’invecchia -
mento della popolazione. Entro il 2050, si prevede che 1 persona su 6 a livello globale avrà 65 anni o più, con nazioni come Giappone, Singapore e Thailandia che registrano un rapido aumento della popolazione anziana.
La ricerca di cibi e bevande che favoriscano una vita più lunga e sana è una tendenza rilevante nelle culture asiatiche, dove il concetto di “cibo come medicina” è radicato. Le categorie di prodotti pratici, come gli snack con benefici funzionali, offrono una scorciatoia verso uno stile di vita sano che si adatta alle routine frenetiche. In Cina, ad esempio, sta riscuotendo grande successo la frutta secca integrata nella dieta quotidiana: più della metà (54%) dei consumatori cinesi di snack salati consuma frutta secca principalmente per tali benefici. E le novità, specie a livello di snack alla frutta secca, hanno registrato un aumento nell’anno fino ad agosto 2024, con claim funzionali che si concentrano sugli antiossidanti, associati a benefici per l’invecchiamento, grazie alla loro capacità di proteggere le cellule dallo stress ossidativo, con i marchi



Per i frequentatori di festival, ecco Engov After Red Hits Flavored Liquid Supplement.

L’olio extravergine di oliva Simpli è prodotto con olive Koroneiki, note come “la regina delle olive” per l’elevato contenuto di antiossidanti.
Negli Stati Uniti cresce l’interesse verso l’olio d’oliva, grazie alla sua reputazione di contenere grassi buoni, e infatti oggi il 59% dei consumatori locali lo percepisce come una scelta sana. Purtroppo, il caldo estremo, gli incendi boschivi e la siccità hanno colpito i raccolti di olive anche negli USA, causando carenze e facendo schizzare alle stelle i prezzi. Ecco perché molti marchi, per evitare il passaggio a oli alternativi, evidenziano e promuovono le tangibili credenziali
che stanno collegando i vantaggi degli antiossidanti con altre note proprietà, come il supporto immunitario e la salute delle ossa, in linea con la tendenza all’invecchiamento sano. Un esempio è la crescente diffusione, in India, dell’uvetta verde afghana, considerata uno dei frutti secchi più nutrienti al mondo, essendo naturalmente ricca di antiossidanti e aiutando a prevenire l’invecchiamento precoce e a promuovere la salute dei capelli.

L’olio extravergine di oliva Terra Mia Coratina, ricco di polifenoli, che prevengono malattie degenerative, complicazioni cardiovascolari, diabete, alcuni tipi di cancro e ipertensione.

funzionali per la salute, così da giustificare prezzi. Dopo un periodo di stagnazione nell’anno precedente, la quota di claim funzionali ha visto un aumento nei lanci di oli. In particolare, tra gli oli funzionali si registra un passaggio dalle formulazioni all’olio di cocco a quelle all’olio extravergine di oliva. La salute cardiovascolare è il claim più importante. I marchi stanno inoltre evidenziando sempre più la presenza di nutrienti benefici, come MUFA e PUFA, noti per l’associazione con la salute del cuore.


In media sono oltre 45mila le particelle di plastica che ingeriamo in un anno, a cui si aggiungono i polimeri respirati; si stima, d’altra parte, una produzione annuale di circa 400 milioni di tonnellate di plastica che, a fronte dei costanti processi di degradazione, diventano biodisponibili in formato micro (10-6 m) e nano (10-9 m) e sono sotto accusa per la capacità patogenetica d’indurre stress ossidativo, infiammazione e apoptosi

delle cellule endoteliali e di altre cellule vasali, provocando alterazioni della funzione e del ritmo cardiaco, fibrosi del miocardio, disfunzione endoteliale e aterosclerosi.
Il nostro corpo riesce a espellerne solo una parte, sembrerebbe tuttavia che una fibra naturale, dotata di una particolare capacità di legame, possa favorire la loro eliminazione e contribuire al benessere generale. Nasce così il primo integratore capace di aumentare del 45% l’espulsione delle microplastiche ingerite attraverso la dieta, il Plastikdren, formulato da Guna. A partire dalla fibra derivata dalla chitina contenuta nel guscio del gambero rosso della Louisiana (Procambarus clarkii).
“Il chitosano da Procambarus clarkii, una volta ingerito e giunto nello stomaco, forma reti molecolari in grado di legare lipidi e microplastiche, limitandone l’assorbimento. Le osservazioni preliminari condotte su un gruppo di volontari sani e a dieta controllata hanno evidenziato che la combinazione tra quest’ultimo e l’acido tartarico riduce l’assorbimento di microplastiche”, spiega Umberto Cornelli della Loyola University di Chicago.
A quali cibi fare attenzione?
Per realizzare le bustine di tè è spesso utilizzato del polipropilene e anche quelle in carta possono contenere microplastiche; per ogni mezza tazza di riso, ci sono dai 3 ai 4 mg di plastica (aumentano nei preparati a base di riso istantaneo); l’acqua in bottiglia di plastica può contenere 325 particelle per litro (se esposte al caldo, le bottiglie rilasciano polimeri); pesci e crostacei sono vittime della contaminazione marina; le api assorbono l’inquinamento dell’aria, acquistare un prodotto biologico da apicoltori locali può ridurre i rischi; le carote soffrono la contaminazione dei terreni; è meglio scegliere il sale non confezionato in pack di plastica; sullo zucchero incidono, oltre al confezionamento i processi industriali; masticando una chewing gum ogni due giorni (circa) si possono ingerire circa 30mila particelle l’anno.

La linea Nutrimix di Life, studiata in collaborazione con i nutrizionisti della Fondazione Umberto Veronesi come risposta funzionale al bisogno di uno snack salutistico, si compone di vari prodotti. Nutrimix Colazione contribuisce a favorire il senso di sazietà attraverso la combinazione bilanciata di noci pecan, uva, mandorle e farro soffiato; il pratico pack da 90 g è studiato per rispondere a tre porzioni di frutta secca, ricche di fibre e vitamina E consigliate anche come spuntini per arricchire yogurt, macedonie, frullati o guarnire pancake. Nutrimix Break, ricco di fosforo, magnesio e vitamina E e privo di glutine, è il mix di noci, mandorle, semi di girasole e uva, per chi cerca uno spuntino nutriente e gustoso. La croccantezza della frutta secca si sposa con la morbidezza dell’uva e con il gusto dei semi. Consumato tale e quale o come arricchitore di piatti e insalate, è ideale per una pausa in ufficio, prima o dopo lo sport, o in viaggio, grazie al doppio formato da 90 g (circa 3 porzioni) e da 30 g (monoporzione per il consumo on the go).
A gestire lo stress si può avvertire maggiore fatica, stanchezza mentale e fisica, irritabilità, cali di concentrazione e difficoltà. Per aiutare l’organismo ad adattarsi, un aiuto arriva dal magnesio, minerale fondamentale per il benessere psicofisico. La forma di glicerofosfato è altamente biodisponibile e delicata sullo stomaco, ideale anche per le persone più sensibili. T-Mag di AVD Reform associa magnesio glicerofosfato a taurina, un amminoacido naturalmente presente nell’organismo, che favorisce la calma mentale, sostiene la funzione cognitiva, migliora la qualità del sonno e contrasta l’irritabilità. Un supporto completo per affrontare la ripresa con più energia e serenità. Un altro grande alleato arriva dal mondo dei funghi medicinali grazie al Reishi (Ganoderma lucidum) un adattogeno naturale conosciuto da secoli nella medicina cinese per il suo effetto riequilibrante sull’asse dello stress e per il supporto al sistema immunitario, utile nei cambi di stagione. Se invece si ha bisogno di un boost per ritrovare il massimo della performance cognitiva, si possono sfruttare le

proprietà nootrope del Reishi in sinergia con caffeina e piante officinali, come Salvia e Bacopa monnieri, ingredienti presenti in Performance Brain di AVD Reform.
Mentre l’Organizzazione
Mondiale della Sanità aggiorna al 5% il dato globale relativo alla popolazione adulta affetta da depressione, la ricerca individua nella dieta un fattore su cui intervenire, sia a scopo preventivo che come trattamento complementare, con potassio e zinco in prima linea. È quanto riporta una ricerca pubblicata su Nutrients: “Comprendere come i singoli componenti della dieta influenzino la salute mentale potrebbe offrire strategie a basso rischio per ridurre il carico della malattia e migliorare il benessere generale”, ha dichiarato Minkook Son, del Dipartimento di Fisiologia del College of Medicine presso la Dong-A University di Busan, Corea del Sud.
Utilizzando i dati sanitari provenienti dal Korean National Health and Nutrition Examination Survey e dal National Health and Nutrition Examination Survey degli Stati Uniti, i ricercatori hanno esaminato l’impatto sul rischio di depressione di sodio, potassio, fosforo, magnesio, ferro, zinco e calcio, tutti minerali biologica-
Il potassio regola i livelli di fluidi all’interno delle cellule, aiuta la contrazione muscolare e contribuisce alla trasmissione dei segnali nervosi nel cervello. Gli esperti raccomandano un’assunzione giornaliera di 2.600-3.400 mg, considerando fattori come sesso, condizioni di salute, livello di attività fisica e stato d’idratazione.
mente rilevanti per i processi coinvolti nella fisiopatologia della malattia, ovvero funzione cerebrale, neurotrasmissione e neuroinfiammazione. Il potassio si rivela un fattore protettivo, con alcune dovute specifiche relative ai modelli alimentari culturali e alle differenze nella biodisponibilità dei partecipanti. In Corea si assume una quantità maggiore di sodio dai piatti fermentati e a base di brodo, che possono interagire con altri nutrienti e influenzare l’umore, e quindi ridurre il rischio di depressione; negli Stati Uniti, un maggiore apporto di zinco da fonti proteiche animali potrebbe avere un ruolo più rilevante nei percorsi neurochimici ed essere, quindi, associato a una minore probabilità di sviluppare la malattia.
Secondo “Free Radical Biology and Medicine”, il succo di barbabietola agirebbe sulla regolazione della pressione sanguigna, grazie alla modifica del microbioma orale. Uno squilibrio tra batteri orali benefici e nocivi potrebbe, infatti, compromettere la conversione del nitrato in ossido nitrico, fondamentale per il buon funzionamento dei vasi sanguigni e, di conseguenza, per la regolazione della pressione arteriosa. In più, la composizione del microbioma orale cambia in modo significativo dopo il consumo del succo ricco di nitrati, ma le variazioni risultano differenti tra giovani (sotto i 30 anni) e anziani (tra i 60 e i 70 anni).
Il gruppo di ricercatori ha utilizzato un metodo di sequenziamento genetico batterico per analizzare quali batteri fossero presenti nella bocca prima e dopo ogni fase dello studio. Dopo l’assunzione del succo ricco di nitrati, nel gruppo più anziano ha osservato una riduzione del batterio orale Prevotella e un aumento del Neisseria; in questo stesso gruppo i valori medi di pressione sanguigna (più elevati all’inizio) si sono ridotti. “Sappiamo che una dieta ricca di nitrati offre benefici e che con l’età si produce meno ossido nitrico, tendendo anche ad avere una pressione sanguigna più elevata, che può essere collegata a complicazioni cardiovascolari come infarto e ictus”, spiega l’autrice Anni Vanhatalo La buona notizia è che esistono molte alternative alla barbabietola ricche di nitrati, quali spinaci, rucola, finocchio, sedano e cavolo riccio.


Il gelato “sportivo”
Esploriamo nei dettagli il rapporto fra gelato artigianale e alimentazione sportiva
Il gelato artigianale sta vivendo un’evoluzione che va ben oltre il piacere di una rinfrescante pausa estiva. Nell’attuale contesto di maggiore consapevolezza alimentare, anche questo prodotto tradizionale può rispondere alle esigenze di consumatori sempre più attenti alla forma fisica e prestazione sportiva.

ROBERTO BIANCHI
Docente presso l’IIS
“Arturo Prever” di Pinerolo, To
Il legame tra gelateria e nutrizione sportiva rappresenta un’opportunità d’innovazione con solide basi scientifiche, considerando la versatilità delle formulazioni e l’ormai presa d’atto che il gelato artigianale è un alimento funzionale che, quando preparato con ingredienti di qualità e bilanciato correttamente, offre un buon apporto

di carboidrati, proteine e grassi in proporzioni adeguate al recupero dopo l’attività fisica.
Per comprendere come il gelato possa inserirsi nell’alimentazione sportiva, analizziamone il profilo nutrizionale base e come ottimizzarlo per rispondere alle esigenze degli sportivi.
Il prodotto artigianale presenta già naturalmente una combinazione interessante di macronutrienti: carboidrati facilmente assimilabili, proteine di qualità (nel caso di gelati a base latte) e grassi. Una composizione che può essere variata: i carboidrati forniscono energia rapidamente disponibile, essenziale sia prima dell’allenamento che nelle fasi di recupero. Le proteine del latte, in particolare,

contengono tutti gli aminoacidi essenziali necessari per recupero e crescita muscolare. Sono definiti “essenziali” quegli amminoacidi che il corpo umano non è in grado di sintetizzare autonomamente in quantità sufficienti per soddisfare i bisogni e che devono quindi essere assunti attraverso l’alimentazione. I grassi, spesso demonizzati, possono rappresentare una fonte energetica importante per attività di lunga durata e contribuiscono alla palatabilità del prodotto.
Andando nel pratico, alcuni gusti tradizionali presentano già caratteristiche interessanti per gli sportivi:
➔ gelato alla nocciola offre un buon apporto di grassi monoinsaturi e vitamina E, con proprietà antiossidanti
➔ gelato al cioccolato fondente contiene flavonoidi che supportano la circolazione sanguigna e l’ossigenazione muscolare ➔ sorbetto ai frutti rossi fornisce antocianine e vitamina C, utili per contrastare l’infiammazione post-esercizio
Un ulteriore vantaggio, spesso sottovalutato, è rappresentato dalla temperatura stessa del gelato . Il freddo offre benefici secondari interessanti per gli sportivi: un effetto vasocostrittore locale che contribuisce al controllo dell’infiammazione, un sollievo termico dopo allenamenti intensi (specie in stagioni calde) e perfino una potenziale regolazione della percezione dello sforzo grazie al piacevole contrasto termico.
La vera innovazione consiste tuttavia nell’ottimizzare deliberatamente questi profili nutrizionali, adattandoli alle fasi dell’attività sportiva e arricchendoli con ingredienti funzionali mirati.
Gli elettroliti sono minerali che formano ioni (particelle cariche) quando si dissolvono nei fluidi corporei. Sono essenziali per numerose funzioni fisiologiche nel nostro organismo.
Elettrolita Simbolo Funzioni principali Fonti alimentari
Sodio Na+ Regolazione volume fluidi, pressione sanguigna, funzione nervosa
Sale da cucina, alimenti processati, formaggi
Potassio K Funzione muscolare e cardiaca, equilibrio idrico Banane, patate, legumi, frutta secca
Calcio Ca2+ Ossa, denti, contrazione muscolare, coagulazione Latticini, verdure a foglia verde, semi
Magnesio Mg2+
Coinvolto in oltre 300 reazioni enzimatiche
Cereali integrali, noci, legumi, verdure verdi
Cloruro Cl- Equilibrio acido-base, digestione Sale da cucina, alghe, olive
Fosfato PO 4 ³- Componente delle ossa, metabolismo energetico
Carne, pesce, latticini, legumi
Bicarbonato HCO3 - Regolazione equilibrio acido-base Prodotto internamente dal corpo
Durante l’attività fisica, specie se intensa o prolungata, perdiamo elettroliti attraverso il sudore. Questo può portare a squilibri elettrolitici che causano crampi muscolari, affaticamento, confusione e, nei casi più gravi, problemi cardiaci. Per questo motivo, soprattutto negli sport di resistenza come la corsa in montagna o il trail running (corsa su sentieri in ambiente naturale con dislivelli significativi), è importante reintegrare non solo i liquidi ma anche gli elettroliti, tramite bevande sportive, integratori specifici o alimenti naturalmente ricchi di questi minerali.
L’efficacia nutrizionale di un alimento dipende non solo dalla sua composizione, ma anche dal momento in cui viene consumato. Nel contesto sportivo, possiamo identificare tre momenti in cui il gelato artigianale si inserisce con formulazioni specifiche.
Pre-allenamento (1-2 ore prima)
Prima dell’attività fisica, l’organismo necessita di energia facilmente disponibile senza appesantire la digestione. Un gelato ideale dovrebbe presentare:
■ alto contenuto di carboidrati a medio indice glicemico (maltodestrine, miele)
■ basso contenuto di grassi per favorire uno svuotamento gastrico rapido
■ moderato apporto proteico
■ eventuali ingredienti energizzanti naturali (guaranà, matcha, maca) Il consumo va considerato preferibilmente con un tempo sufficiente per la digestione. Grazie ad un equilibrio tra carboidrati e proteine può fornire energia facilmente utilizzabile durante l’attività fisica, specialmente per chi pratica sport di resistenza. Un esempio è un sorbetto a base di frutta e miele, con l’aggiunta di maltodestrine e un tocco di zenzero per favorire la digestione.
Durante l’attività (per sport di resistenza oltre i 90 minuti)
Durante attività prolungate come ciclismo, corsa in montagna o triathlon, il gelato rappresenta un’al-
ternativa ai gel energetici, a patto che sia disponibile sul percorso. In questo caso, il focus è su:
✔ carboidrati semplici per energia immediata
✔ elettroliti per compensare quelli persi con la sudorazione
✔ consistenza molto morbida per facilitare l’assunzione
✔ porzioni ridotte (40-60 g)
Un sorbetto ricco di fruttosio con l’aggiunta di sali minerali può essere un’ottima soluzione per reintegrare energia ed elettroliti durante lo sforzo.
Post-allenamento (entro 30-60 minuti)
La finestra anabolica post-allenamento è il momento ideale per un gelato formulato per il recupero muscolare. In questa fase, l’organismo necessita di:
● proteine complete per la riparazione muscolare (7-15 g per porzione)
● carboidrati per ricostituire le riserve di glicogeno
● antiossidanti per contrastare lo stress ossidativo indotto dall’esercizio.
Nel recupero, un rapporto tra carboidrati e proteine di circa 3:1 o 4:1 è considerato efficace per ripristinare le riserve energetiche e favorire la riparazione muscolare. Il gelato artigianale a base latte, grazie al naturale contenuto di carboidrati e proteine, risulta gradevole, anche come esperienza gustativa più appagante. Un esempio efficace è un gelato alla vaniglia o cacao con proteine del siero del latte, arricchito con frutta secca e miele.
Ma quali sono gli ingredienti chiave per la corretta formulazione di un gelato performante, privilegiando quelli che apportano benefici specifici per l’attività fisica senza compromettere la struttura e il gusto del prodotto finale?

Quando si parla di ottimizzare il recupero muscolare dopo l’attività fisica, un concetto da non trascurare è quello della finestra anabolica, ovvero il periodo di tempo successivo all’allenamento durante il quale il corpo è recettivo all’assunzione di nutrienti, specie proteine e carboidrati, per favorire la riparazione e la crescita delle fibre muscolari danneggiate e per ripristinare le riserve di energia (glicogeno) utilizzate durante l’esercizio. Sebbene le ricerche più recenti abbiano sfumato l’idea di una “finestra” temporale rigida di pochi minuti, è riconosciuto che un apporto nutrizionale tempestivo post-allenamento può offrire benefici significativi. In questo momento, i muscoli sono più sensibili all’insulina, ormone che facilita l’assorbimento di glucosio e aminoacidi, i “mattoni” per la ricostruzione muscolare. Consumare alimenti che combinano proteine di alta qualità e carboidrati digeribili entro un paio d’ore dal termine dell’esercizio contribuisce a:
● stimolare la sintesi proteica muscolare, fornire gli aminoacidi necessari per riparare e costruire nuove fibre muscolari, favorendo adattamento all’allenamento e crescita muscolare
● rifornire le scorte di glicogeno, reintegrare le riserve di carboidrati in muscoli e fegato, essenziali per il recupero energetico e per preparare il corpo alla successiva sessione di allenamento
● ridurre il catabolismo muscolare aiutare a limitare la degradazione delle proteine muscolari che può verificarsi dopo un esercizio intenso.
In quest’ottica, anche un gelato artigianale, se scelto con attenzione agli ingredienti (ad esempio, con un buon contenuto proteico derivante da latte e carboidrati da frutta o zuccheri), è una strategia nutrizionale post-allenamento interessante per alcuni sportivi. La digeribilità e la palatabilità rendono anche più gradevole l’assunzione di nutrienti. L’apporto nutrizionale totale nell’arco della giornata rimane l’elemento più importante per recupero e crescita muscolare a lungo termine, ma ottimizzare l’alimentazione nella fase post-allenamento è un vantaggio aggiuntivo.
Dallo studio condotto da YouGov nel maggio 2024, il 96% degli italiani dichiara che è importante bere la giusta quantità di acqua, ma solo il 56% sa che è necessario berne almeno 2 litri al giorno e il 64% ne beve meno della quantità raccomandata. Per quanto riguarda l’integrazione di sali minerali, solo il 19% degli intervistati dichiara di usarli settimanalmente e solo il 12% assume bevande per sportivi già formulate. Liquid I.V., brand di Unilever, è l’integratore alimentare scientificamente formulato per migliorare l’idratazione, con una combinazione precisa di carboidrati ed elettroliti, e l’energia delle vitamine B3, B5, B12 e C. Gli elettroliti, minerali, come sodio e potassio che si perdono con la sudorazione, insieme a 11 g di zuccheri, in particolare glucosio, favoriscono l’assorbimento di acqua nell’organismo per un’idratazione rapida. È disponibile in confezioni da 10, 6 e 3 stick da sciogliere, ciascuno, in 500 mL di acqua naturale, e in tre varianti di gusto: Lemon Lime, mix di limone e lime, dissetante e rinfrescante; Fragola; Frutto della Passione, per una variente esotica.
Se con l’età, forza muscolare, massa e funzionalità diminuiscono, una routine che includa anche attività aerobiche aiuta a mantenere il corpo in forza, migliora l’equilibrio e la mobilità, rivelandosi efficace contro il rischio di cadute e lesioni. Esercizi come la camminata tallone-punta (con le braccia distese e lo sguardo in avanti per 10-20 passi), sollevamenti delle gambe (da seduti, stendere una gamba senza bloccare il ginocchio, puntare le dita verso l’alto, mantenere per 1 secondo e

Dal 2012 sul mercato americano e recentemente lanciato in Australia, Brasile, Canada, Cina, India, Messico, Regno Unito, dal 2024 Liquid I.V. è distribuito in Italia da Equilibra nei supermercati, in farmacia e online.

abbassare lentamente) e rotazioni della testa (da un lato all’altro, poi su e giù per 30 secondi, eretti con i piedi alla larghezza dei fianchi), spostare il peso su un lato sollevando l’altro piede (in posizione per circa 30 secondi) e restare in equilibrio su una gamba (in piedi, fermi fino a 30 secondi). È utile anche restare in piedi davanti a un gradino basso, toccarlo con un piede e tornare al pavimento; in piedi davanti a una sedia, sedersi lentamente, poi spingere sui talloni per alzarsi senza slanciare il busto in avanti. Usando un supporto, se necessario. Il Centers for Disease Control and Prevention degli Stati Uniti raccomanda 150 minuti di esercizio aerobico a settimana agli over 65 anni e a tutti gli adulti di prevedere almeno 2 giorni di allenamento di forza per prevenire le cadute. Per chi è alle prime armi con l’attività fisica, anche solo 15 minuti di camminata alcune volte a settimana possono migliorare la forma fisica, optando per alternative come allenamento funzionale, yoga o tai chi.

OrtoRomi freddo, arricchiti con sostanze utili al corretto funzionamento dell’or ganismo, senza coloranti, né zuccheri aggiunti. La versione pera, fragola, arancia rossa e frutto della passione contiene le proteine idrolizzate del pisello, ed è indicata per sostenere la forza muscolare; favorisce l’equilibrio intestinale e rafforza le difese immunitarie il gusto mela, banana, guava rosa e farina di avena, con l’aggiunta di 1 miliar do di cellule vive, tra cui il probiotico BC30 ( Contrasta la stanchezza e aiuta a reintegrare i liquidi persi durante l’at tività fisica l’estratto mela, arancia, kiwi giallo, limone e zenzero, con
La bevanda funzionale Fruit Pro con un’alta percentuale di frutta e un importante apporto nutri zionale, per ogni confezione da 250 mL. Nei gusti ACE e Ananas, assicura infatti 20 g di proteine, utili alla crescita e al manteni mento della massa muscolare, mentre un’abbondante dose di vi tamina C sostiene il metabolismo e rafforza le difese immunitarie.







Con una gestione ottimale e competenze specifiche, allevare insetti può diventare un’opportunità sostenibile ed economica

Quando si parla di insetti commestibili, spesso uno dei commenti è: “Ci mettono la farina di grillo senza dircelo”. Voglio chiarire subito una cosa: questa idea non solo è falsa, ma anche piuttosto assurda. Non avrebbe senso da un punto di vista economico, perché la farina di insetti è estremamente più costosa rispetto alla farina tradizionale, considerando che questa costa tra 0,50 e 2 euro al kg, mentre quella di insetti parte da circa 4-5 e può superare anche i 70 euro al kg. Insomma, nessun produttore sarebbe così ingenuo da condurre un’operazione del genere. Storicamente, in tempi difficili come in guerra, la farina veniva adulterata con materiali molto più economici come

gesso, caolino o farine tipo patate o crusca. In passato, molte startup hanno cercato di creare allevamenti di insetti commestibili. Purtroppo, quasi tutti questi progetti pilota si sono bloccati per due motivi principali:
- l’approvazione degli insetti come alimenti è arrivata troppo lentamente;
- predisporre un allevamento piccolo non è conveniente, a meno che non si producano snack, pasta o barrette in quantità limitate.
Storia e diffusione dell’allevamento
L’allevamento commerciale di vermi commestibili della farina, mealworms, negli USA risale agli anni ‘50, originariamente destinato all’acquacoltura, per la nutrizione dei pesci ornamentali e sportivi. A partire dagli anni ‘70, grazie all’espansione del mercato del pet food e all’incremento del numero di appassionati di rettili, anfibi e uccelli domestici, il loro impiego come alimento vivo ha subìto un netto

“ “
I mealworms presentano livelli elevati di potassio, zinco, ferro e selenio. Il contenuto proteico è paragonabile a quello della carne bovina, mentre gli acidi grassi Omega-3 sono simili a quelli presenti nei pesci grassi e superiori rispetto a quelli di carne suina o bovina
aumento. Dagli anni ‘90 in poi, l’interesse verso fonti proteiche alternative e sostenibili ne ha ulteriormente accelerato la diffusione anche nel settore alimentare umano. In Cina la pratica di allevamento di Tenebrio molitor è molto diffusa da decenni, sia per il consumo umano, specie in prodotti trasformati come farine proteiche e snack salutistici, che per uso zootecnico, fra acquacoltura, avicoltura e alimentazione di rettili e piccoli mammiferi. Il Tenebrio molitor è un coleottero marrone lungo circa 15-20 mm, con ali membranose ricoperte da elitre dure e protettive. Spesso è considerato un infestante dei magazzini alimentari, poiché le larve contaminano derrate come farine e cereali tramite escrementi e detriti, causando alterazioni qualitative. In natura predilige ambienti caldi, bui e umidi, quali tronchi marci e spazi sotto le pietre. Altre specie simili allevabili sono il Tenebrio obscurus (caratterizzato da una livrea più scura), il Tribolium castaneum (più piccolo, 3-4 mm, color rosso-marrone) e lo Zophobas morio (super mealworm), più grande e con esigenze nutrizionali leggermente diverse.
I mealworms presentano livelli elevati di potassio, zinco, ferro e selenio. Il contenuto proteico è paragonabile a quello della carne bovina, mentre gli acidi grassi Omega-3 sono simili a quelli presenti nei pesci grassi e superiori rispetto a quelli di carne suina o bovina.

” In termini di sostenibilità ambientale, i mealworms sono efficienti: la superficie necessaria per produrre una quantità equivalente di proteine è ben inferiore rispetto a bovini, maiali o latticini
“
La durata del ciclo vitale completo può variare notevolmente (da 3 mesi fino a oltre un anno), in base alle condizioni ambientali e nutrizionali. Temperature ideali sono comprese tra 25 e 30°C, con umidità relativa del 50-70%.

Le larve si alimentano di crusca di cereali e verdure fresche, che forniscono l’acqua necessaria (contenuto ottimale 18%). È fondamentale evitare l’aggiunta diretta di acqua per prevenire lo sviluppo di muffe tossiche. Le verdure fresche devono essere lavate per eliminare residui di pesticidi, dannosi per gli insetti. L’integrazione di proteine derivanti da lievito di birra migliora significativamente le performance di crescita. In termini di sostenibilità ambientale, i mealworms sono efficienti: la superficie necessaria per produrre una quantità equivalente di proteine è ben inferiore rispetto a bovini, maiali o latticini.
La metodologia più diffusa utilizza vassoi in plastica, che sono pratici, ma richiedono manutenzione costante, separazioni frequenti delle uova e pulizie periodiche. Un sistema più avanzato prevede reti sottili (maglia di 0,5 mm) per facilitare la separazione delle uova dalle deiezioni. Inizialmente, per circa 4-5 settimane, le larve vanno mantenute in vassoi senza rete.
Ogni femmina depone da 270 a 500 uova minuscole, difficili da individuare a occhio nudo. La separazione delle femmine ogni 3-5 giorni permette una produzione più sincronizzata e gestibile.
La fase larvale dura da 45 a 90 giorni, seguita dalla fase pupale (2-3 settimane), durante la quale è necessario separare frequentemente larve e pupe per evitare cannibalismo. In condizioni di temperatura bassa, la fase di pupa può durare fino a 9 mesi.
Costi di mercato e fattori determinanti
I prezzi di vendita delle larve essiccate variano da 4-5 a oltre 50 $/kg, influenzati da fattori come metodologia di allevamento, certificazioni, scala produttiva e Paese di origine. Nel mio allevamento pilota, non ottimizzato, il costo raggiunse 70 €/kg. Avevo ipotizzato che, con un allevamento automatizzato su circa 500 m2, avrei potuto abbassare i costi a circa 9 €/kg.
Anche con costi elevati (50-70 €/kg), l’uso della farina di insetti in prodotti finiti (come snack o barrette, con dosaggi tipici del 10-12%) resta economicamente valido, grazie al valore aggiunto di sostenibilità e innovazione che consente di premiare il prodotto finale.
Allevare insetti richiede quindi attenzione ai dettagli tecnici e investimenti iniziali consistenti. Tuttavia, con una gestione ottimale e competenze specifiche, può diventare una valida opportunità sostenibile ed economica.
Il materiale per costruire l’allevamento si può reperire in rete così, come si trovano produttori di macchine per la separazione di uova e insetti durante la fase di sviluppo. Si trovano anche macchine che essiccano e macinano gli insetti.
L’olio extra vergine di oliva (EVOO) non è solo un condimento amato per il suo sapore e aroma distintivi, ma è universalmente riconosciuto come un pilastro fondamentale della dieta mediterranea e un vero e proprio alimento funzionale La sua posizione alla base della piramide alimentare mediterranea è giustificata non solo dall’importanza storica nell’agricoltura e nella cucina dei Paesi che si affacciano sul Mediterraneo, ma soprattutto
dalle consolidate prove scientifiche dei benefici associati al consumo regolare. A differenza di altri oli vegetali che richiedono processi chimici per l’estrazione o la raffinazione, l’EVOO si ottiene esclusivamente tramite processi fisici, come la spremitura del frutto dell’olivo, senza l’uso di solventi chimici o trattamenti diversi da lavaggio, decantazione, centrifugazione e filtrazione. Questo metodo di produzione permette di preservare un ricco patrimonio


FRANCESCA ORSINI Biologa Nutrizionista

di composti bioattivi naturali che sono i veri responsabili delle sue straordinarie proprietà salutistiche.
con proprietà antiossidanti, protettive per la pelle, anti-infiammatorie e potenzialmente antitumorali;
- tocoferoli (Vitamina E): potenti antiossidanti che contribuiscono alla stabilità e ai benefici per la salute dell’olio.
L’EVOO, grazie alla sinergia dei suoi componenti, agisce su molteplici meccanismi patologici, offrendo protezione contro un’ampia gamma di malattie croniche.
“ “
I polifenoli contribuiscono alla protezione dei lipidi ematici dallo stress ossidativo, purché l’olio contenga un minimo di 250 mg/kg di polifenoli totali
La maggior parte del peso totale dell’EVOO (98-99%) è costituita da acidi grassi, in particolare acidi grassi monoinsaturi (MUFA), tra cui l’acido oleico (OA) è il componente principale (55-83%) che, da solo, contribuisce a numerosi effetti benefici sulla salute cardiovascolare, come la riduzione della pressione sanguigna e il miglioramento del profilo lipidico. Tuttavia, sono i composti “minori”, presenti in quantità più piccole (1-2% del peso totale), a conferire le proprietà uniche e a distinguerlo dagli oli raffinati. Questi includono:
- polifenoli: un gruppo eterogeneo di oltre 36 composti fenolici, tra cui i più studiati sono l’idrossitirosolo (HT), il tirosolo (Tyr), l’oleuropeina (Olp) e l’oleocantale (Olc). Sono responsabili di gran parte delle proprietà anti-infiammatorie, antiossidanti e neuroprotettive dell’olio, e contribuiscono al suo sapore amaro e piccante;
- squalene: triterpene naturalmente presente in quantità significative,
- Effetti anti-infiammatori: i polifenoli, specie oleocantale e idrossitirosolo, dimostrano potenti effetti anti-infiammatori, azione cruciale nella prevenzione e gestione di condizioni croniche associate all’infiammazione, comprese le malattie cardiovascolari e metaboliche.
- Potere antiossidante: i polifenoli sono ottimi antiossidanti, capaci di neutralizzare i radicali liberi, proteggere i lipidi (in particolare le LDL) dall’ossidazione e migliorare l’attività degli enzimi antiossidanti endogeni. Questa attività è fondamentale per contrastare lo stress ossidativo, fattore chiave nell’invecchiamento e nello sviluppo di malattie croniche.
- Salute cardiovascolare: i MUFA e i polifenoli contribuiscono a migliorare il profilo lipidico, riducendo i livelli di colesterolo LDL (“cattivo”) e trigliceridi, e aumentando il colesterolo HDL (“buono”), migliorando anche la funzionalità delle HDL e proteggendo le LDL dall’ossidazione. Inoltre, l’EVOO contribuisce a ridurre la pressione sanguigna, migliorare la funzione endoteliale (aumentando la biodisponibilità di ossido nitrico) e diminuire la rigidità arteriosa. Il consumo è associato a una riduzione
del rischio di eventi cardiovascolari come infarto del miocardio e ictus. E contribuisce a prevenire la progressione della placca aterosclerotica e a migliorare la funzione piastrinica, riducendo l’aggregazione.
- Gestione di peso e obesità: in particolare il consumo di olio ad alto contenuto fenolico può favorire la riduzione del peso corporeo, del BMI, della circonferenza vita e del grasso viscerale, prevenendo l’aumento di peso nel tempo. Si ritiene che ciò avvenga modulando il metabolismo lipidico, l’ossidazione dei grassi e la regolazione dell’appetito,

oltre a ridurre l’infiammazione di basso grado associata all’obesità.
- Salute del fegato: l’HP-EVOO ha mostrato effetti benefici, riducendo l’accumulo di grasso, l’infiammazione e il danno ossidativo, e migliorando i livelli degli enzimi epatici e la rigidità del fegato, in particolare nei pazienti con steatosi epatica non alcolica.
- Neuroprotezione e salute cognitiva: ricco di MUFA e polifenoli (come oleuropeina e idrossitirosolo), esercita effetti neuroprotettivi, proteggendo i neuroni dallo stress ossidativo e dall’infiammazione, fattori cruciali nel declino cognitivo e nelle malattie neurodegenerative come l’Alzheimer.
- Longevità e anti-invecchiamento: il consumo regolare è stato associato a una maggiore longevità e alla riduzione del rischio di malattie croniche legate all’età. Si ritiene che moduli i “segni distintivi dell’invecchiamento”, come lo stress ossidativo, l’infiammazione, l’instabilità genomica e la senescenza cellulare, contribuendo a un invecchiamento più sano.
Per massimizzare i benefici per la salute è fondamentale scegliere un olio extra vergine di oliva di alta qualità, in particolare quelli con un elevato contenuto di polifenoli. L’Autorità Europea per la Sicurezza Alimentare (EFSA) ha autorizzato un’indicazione sulla salute che afferma che i polifenoli dell’olio d’oliva contribuiscano alla protezione dei lipidi ematici dallo stress ossidativo, purché l’olio contenga almeno 5 mg d’idrossitirosolo e suoi derivati per 20 g di olio, o un minimo di 250 mg/kg di polifenoli totali.
Il contenuto di polifenoli nell’EVOO può variare notevolmente a seconda di fattori come la cultivar dell’oliva, le condizioni climatiche, le tecniche di coltivazione e, soprattutto, i metodi di produzione e, infine, di conservazione. Tecnologie innovative come la denocciolatura delle olive prima della spremitura sono state studiate per migliorare la qualità dell’olio, aumentando il contenuto di polifenoli e migliorando le caratteristiche sensoriali. Questo perché l’eliminazione del nocciolo, ricco di enzimi ossidativi come la perossidasi, riduce la degradazione dei polifenoli durante il processo di estrazione, portando a oli con maggiore stabilità ossidativa e un profilo nutrizionale superiore.
L’eliminazione
del nocciolo, ricco di enzimi ossidativi, riduce la degradazione dei polifenoli, portando a oli con maggiore stabilità ossidativa e profilo nutrizionale superiore
“ “
Ai sensi del citato regolamento, un “novel food è considerato qualunque alimento non utilizzato in misura significativa per il consumo umano nell’Unione prima del 15 maggio 1997, a prescindere dalla data di adesione all’Unione degli Stati membri, che rientra in almeno una delle categorie definite dal regolamento”.

Per capire se una pianta o il suo estratto possa essere considerato un novel food è cruciale verificarne il consumo significativo nell’Unione prima del 1997 e, in caso positivo, stabilire anche se questo riguardasse solo integratori alimentari o anche altri alimenti. Se una parte della pianta, come il fiore, non è stata consumata prima di quella data, sarà considerata come un novel food non autorizzato, an-
che se il frutto è not novel. Il Novel Food Catalogue della Commissione Europea può essere utile, ma non sempre è dettagliato, nonostante i recenti aggiornamenti più attenti a concentrazioni e tipi di estratti, e, dal punto di vista del diritto, non legalmente vincolante. Le liste nazionali, come quella italiana, offrono indicazioni, ma è essenziale confermare che l’uso del preparato sia autorizzato anche per altri alimenti, non


solo per gli integratori alimentari, a seconda dell’uso che s’intenda fare della pianta. La responsabilità di dimostrare lo status di not novel food ricade sull’operatore, e i novel food non autorizzati sono considerati non sicuri per la salute e quindi a rischio di ritiro dal mercato, a meno che l’operatore non sia in grado di dimostrarne not novel food status. Diversi Stati Membri hanno pubblicato nel tempo delle liste nazionali di piante ammesse negli alimenti, anche se la maggior parte di queste è limitata all’uso negli integratori alimentari. La lista italiana, emessa per Decreto Ministeriale, si riferisce in maniera esplicita agli integratori alimentari ed è importante considerare che alcune piante elencate possono essere considerate novel food, se usate in alimenti diversi dagli integratori alimentari Tuttavia, alcune precauzioni e avvertenze dovrebbero essere tenute in considerazione anche rispetto ad alimenti diversi dagli integra-
tori alimentari. Alcuni stati membri hanno disciplinato l’aggiunta di altre sostanze alle bevande e questo potrebbe, in effetti, limitare l’uso di alcune piante in questi alimenti, anche se – quando non sussistono ragioni di salute pubblica – il principio del mutuo riconoscimento può essere applicato in alcune circostanze. L’Italia ha inoltre ulteriori discipline per l’uso degli estratti di piante attraverso il D.P.R. 719/1958 che ne consente esplicitamente l’uso nelle bevande. Inoltre, le diverse applicazioni nazionali del diritto europeo armonizzato sono difficili da superare, così come la comprensione nella classificazione tra farmaco e alimento che riguarda principalmente i botanicals in alcuni stati membri, come la Germania. Naturalmente, laddove esistano delle restrizioni imposte dal diritto europeo, come, ad esempio, per le preparazioni a base di foglie di aloe contenenti idrossiantraceni, queste prevalgono su eventuali norme nazionali. Nonostante, infatti,
“ La responsabilità di dimostrare lo status di notnovelfood ricade sull’operatore, e i novel food non autorizzati sono considerati non sicuri per la salute e quindi a rischio di ritiro dal mercato, a meno che l’operatore non sia in grado di dimostrarne notnovelfoodstatus
“
il diritto europeo regoli, come visto, vari aspetti della materia, la responsabilità di classificare un prodotto come alimento o medicinale spetta ai singoli Stati Membri, anche se la Corte di Giustizia ha nel tempo indicato dei confini stabilendo, per esempio, che un alimento possa avere effetti fisiologici, ma solo le sostanze farmacologicamente attive possono essere classificate come medicinali. Così, uno stesso prodotto con lo stesso estratto vegetale può essere considerato alimento in una nazione e medicinale in un’altra. Nella pratica, per dimostrare che un alimento con estratti vegetali sia un farmaco non autorizzato, bisogna valutare se la quantità di pianta è quella normalmente consumata nella dieta e se l’effetto fisiologico è apprezzabile, tenendo conto dei rischi associati. Infine, il diritto europeo impone che le sostanze utilizzate negli alimenti e, conseguen-
temente gli alimenti finiti ottenuti con esse siano sicuri per la salute. Questo prevede, oltre a quanto discusso, che questi siano conformi ad ulteriori criteri di sicurezza e qualità, alcuni disciplinati da leggi specifiche, tra cui l’irradiazione, la presenza di OGM, di contaminanti come metalli pesanti, diossine, alcaloidi pirrolizidinici, idrocarburi policiclici aromatici, ma anche rispetto ai pesticidi, alle specifiche microbiologiche, ai solventi, che rispettino la tracciabilità e altre prescrizioni, garantendo che l’alimento sia sicuro per il consumo come richiesto dal Regolamento (CE) 178/2002
In particolare, rispetto ai metaboliti secondari, è importante tenere presente che, dove il loro controllo non sia previsto dal diritto europeo o nazionale, l’operatore ha l’obbligo d’identificarli e controllarli sulla base del generico obbligo di commercializzare un alimento sicuro.

Presentato da:

in-Vitality è l’evento B2B di riferimento che si concentra sul dinamico settore degli integratori alimentari e del benessere, dove l’Italia detiene una quota dominante del 26% delle vendite europee. L’evento, situato a Milano, capitale della moda dell’innovazione e fulcro degli affari, rappresenta un punto di riferimento fondamentale per il settore.

Come ben sappiamo, la celiachia è una malattia autoimmune che colpisce l’intestino tenue e richiede una dieta rigorosa priva di glutine, che rappresenta l’unica terapia efficace. Tuttavia, questa dieta comporta spesso un apporto ridotto di fibra alimentare, fondamentale per la salute digestiva e generale. I prodotti senza glutine, infatti, tendono a contenere meno fibre rispetto a quelli tradizionali, anche a causa dell’uso prevalente di amidi per migliorarne consistenza e gradimento. Questo deficit può favorire problemi digestivi comuni tra i celiaci, come la stitichezza e una minore sazietà. Gli alimenti funzionali offrono oggi soluzioni

“
Un intestino regolare e un microbiota sano contribuiscono a ridurre l’infiammazione sistemica, un vantaggio importante per chi ha la celiachia
“

innovative, introducendo fonti di fibra senza glutine in grado di migliorare significativamente la qualità della vita dei celiaci.
La fibra alimentare è un carboidrato complesso non digeribile, suddivisa in fibra solubile e insolubile, ciascuna con benefici distinti.
La fibra insolubile, presente ad esempio nella crusca di riso, nelle bucce di frutta e verdura e in alcu-

ni legumi, aumenta il volume delle feci e accelera il transito intestinale, favorendo regolarità e salute del colon.
La fibra solubile, che si trova in legumi, mele, agrumi e alcune verdure, assorbe acqua e forma un gel che rallenta lo svuotamento gastrico, aumenta il senso di sazietà e aiuta a controllare glicemia e colesterolo. Agisce inoltre da prebiotico, nutrendo i batteri benéfici del microbiota intestinale, cruciale per le difese immunitarie e la digestione. Nei celiaci, un adeguato apporto di entrambe le fibre è ancora più importante, poiché l’infiammazione cronica e i danni intestinali alterano il microbiota: ecco perché il ruolo prebiotico della fibra solubile è prezioso.
La ricerca nutrizionale si sta concentrando su nuove fonti di fibra prive di glutine e molti prodotti una volta di nicchia sono ora facilmente reperibili. Tra questi spiccano gli pseudo-cereali come quinoa, amaranto e grano saraceno, naturalmente privi di glutine e ricchi di fibra. La quinoa apporta sia fibra solubile che insolubile e aiuta a regolare l’intestino e la sazietà. Il grano saraceno, tecnicamente non un cereale, fornisce
L’industria alimentare sta facendo grandi progressi per offrire prodotti sempre più completi e nutrienti. Per massimizzare i benefici, è consigliabile farsi guidare da un dietologo o nutrizionista esperto in celiachia, per un piano personalizzato ed efficace
“ “

fibra insolubile e contiene rutina, un antiossidante. L’amaranto è ricco di fibra e proteine, con proprietà prebiotiche. Questi ingredienti migliorano il valore nutrizionale di pane e pasta senza glutine: sempre idonei se in chicchi, con la dicitura “senza glutine” in etichetta se in forma di farina.
Tra gli alimenti più comuni ci sono anche i legumi come lenticchie, ceci e fagioli, ricchi di fibre solubili e insolubili, oltre che di proteine vegetali e micronutrienti. Spesso trascurati nella dieta senza glutine, sono invece preziosi e possono essere usati interi in zuppe e insalate o come farine (certificate senza glutine) nei prodotti da forno. Aiutano a promuovere sazietà e stabilità glicemica.
Anche frutta e verdura sono fondamentali. Tra le verdure, quelle a foglia verde scuro, i broccoli e i cavolfiori sono ricchi di fibra insolubile; tra i frutti, mele e pere (con la buccia) offrono ottima fibra solubile. Consumati crudi non danno problemi, mentre per i prodotti trasformati serve l’indicazione “senza glutine”. Attenzione: gli estratti, eliminando la fibra, sono meno utili a questo scopo.
Altre fonti di fibra eccellente sono la cuticola di psillio, i semi di chia e lino e la frutta a guscio. Questi alimenti sono ricchi di fibra solubile e insolubile, acidi grassi omega-3 e nutrienti. La cuticola di psillio è una delle fonti più concentrate di fibra solubile ed è molto usata come integratore o ingrediente per migliorare la consistenza dei prodotti da forno gluten free. I semi di chia e di lino , una volta idratati, formano un gel ricco di fibra utile per sazietà e transito intestinale; possono essere aggiunti a yogurt, frullati e insalate o usati come legante nei dolci. La frutta a guscio , come mandorle,
noci e nocciole, se consumata con la pellicina e appena sgusciata, apporta fibra, grassi buoni e proteine. Andrebbe conservata in luogo fresco e asciutto, per proteggere i grassi contenuti.
Questi accorgimenti fanno bene a tutti, ma i benefici per i celiaci sono ancora più significativi. La fibra insolubile contrasta la stitichezza, frequente nei celiaci a causa della scarsa assunzione di cereali integrali. Le fibre con azione prebiotica aiutano a riequilibrare la flora intestinale compromessa, migliorando digestione e assorbimento. Inoltre, rallentando lo svuotamento gastrico, la fibra solubile favorisce la sazietà. Con il ripristino della salute intestinale, i celiaci spesso tendono a prendere peso, quindi la fibra può essere d’aiuto. Un intestino regolare e un microbiota sano contribuiscono anche a ridurre l’infiammazione sistemica, un vantaggio importante per chi soffre di celiachia.
Aumentare l’apporto di fibra per un celiaco richiede attenzione e consapevolezza. È utile scegliere prodotti senza glutine fortificati e controllare che contengano fibre come psillio o inulina, includere regolarmente pseudo-cereali nei pasti, consumare legumi più volte alla settimana, aumentare frutta e verdura, variando colori e tipologie, e usare semi e frutta a guscio in modo quotidiano, aggiungendoli a colazioni, snack e insalate.
La fibra alimentare funzionale senza glutine non è un elemento accessorio, ma un pilastro essenziale per la salute del celiaco. Integrare nella dieta fonti varie di fibra solubile e insolubile migliora digestione, sazietà e benessere del microbiota intestinale. L’industria alimentare sta facendo grandi progressi per offrire prodotti sempre più completi e nutrienti.
Una nuova generazione di alternative vegetali alla carne (plant-based meat alternatives) entra nel mercato accanto a tofu, tempeh, seitan e proteine vegetali testurizzate. I PBMA imitano

le caratteristiche sensoriali e il profilo nutrizionale dei loro omologhi a base di carne (in particolare rossa), grazie all’arricchimento con nutrienti carenti nelle diete vegetali, come ferro, zinco e vitamina B12. Un articolo pubblicato su “Frontiers in Nutrition” riporta alcune linee guida nutrizionali a loro dedicate, confermando il dibattito in corso sulla salubrità delle PBMA, che secondo la classificazione NOVA (a causa della formulazione e dei processi di trasformazione) rientrano nella categoria degli alimenti ultra-processati, sollevando qualche cautela: sono inoltre spesso ricche di sodio e con livelli inferiori di fibre, amido resistente e polifenoli, tipicamente associati ai benefici delle diete a base vegetale. Le evidenze suggeriscono che, pur non offrendo tutti i benefici dei legumi integrali, le PBMA presentano vantaggi per salute e ambiente. Per la maggior parte delle persone, una loro porzione giornaliera s’inserisce quindi all’interno di un’alimentazione sana, e anche un consumo maggiore può risultare compatibile, specie per chi ha un più alto fabbisogno di proteine e/o calorie.
Nel 2020, il Gruppo Granarolo ha lanciato l’alternative meat Unconventional, novità per il mercato italiano rivolta ai flexitariani che seguono un percorso di riduzione del consumo di proteine animali a favore di quelle vegetali. Presto le referenze fresche si sono arricchite (salsiccia, cotolette, ribs, nuggets al gusto pesce e falafel) e oggi il marchio entra nel mondo della gastronomia vegetale e ingredientistica con referenze a base di soia. Silken tofu è ricco in proteine, biologico e senza glutine, dalla consistenza morbida, per ricette dolci e salate, e creme. I cubetti di tofu si declinano in versione mediterranea e in salsa teriyaki, da scaldare e pronti in pochi minuti, biologici e ricchi in proteine. Gli straccetti si caratterizzano per il gusto manzo, anch’essi ricchi in proteine, fonte di fibre, e simili alla carne per consistenza, grazie alla tecnologia di estrusione a umido.
Infine, i mini burger nei gusti spinaci e
ceci e barbabietola e cannellini hanno una panatura di spinaci e barbabietola, e non contengono conservanti.

“
Classe 1998, sono figlia di Antonio Capuano e Carmela Moffa: grazie a loro, rinomati professionisti, mi sono appassionata presto al mondo della pasticceria, affiancandoli sin da piccola”. Così si presenta Camilla Capuano che, dopo il diloma di perito agrario, si è iscritta alla Facoltà di Tecnologie Alimentari presso l’Università Alma Mater Studiorum di Bologna. E prosegue: “Durante il percorso, ho avuto l’occasione di entrare in contatto con varie aziende del settore agroalimentare, sia in Italia che all’estero, e nel corso degli studi accademici ho avuto la possibilità di ampliare le competenze tecniche svolgendo un tirocinio presso Carpigiani, all’interno del Laboratorio di Analisi e Microbiologia, allargando il focus alle macchine industriali e alle

tecnologie applicate alla produzione di gelato artigianale e soft, nonché alla tecnologia delle miscele di collaudo. Non meno importante è stata la collaborazione con alcune aziende artigianali, occupandomi della creazione di linee di prodotti free from, incentrati sull’intolleranza al glutine e al lattosio”. Da qui l’ingresso nel mondo della docenza presso alcune scuole del settore già nel 2021.
Oggi Camilla lavora all’estero come quality manager in un’industria alimentare: “Il mio percorso ha plasmato in me non solo una passione, ma un autentico amore per il campo alimentare, trasformandolo in una vera ragione di vita. Ogni giorno, m’impegno a garantire la massima qualità e sicurezza dei prodotti, applicando le competenze acquisite negli anni. La

responsabilità di assicurare che gli standard più elevati siano mantenuti è diventata una parte fondamentale della mia missione, soprattutto per quanto riguarda prodotti free from”.
Cosa significa free from e come ti sei appassionata allo studio dell’argomento?
Per free from s’intende l’insieme di prodotti di cui si evidenzia l’assenza di alcuni elementi come glutine, lattosio, zucchero, additivi e così via. Il mio interesse cominciò quando scoprii un’intolleranza al glutine e si sviluppò per la necessità di ricalibrare la mia alimentazione e di prestare attenzione a tutto ciò che acquistavo. Sono rimasta colpita dall’offerta ridotta e dalla scarsa diversificazione di prodotti gluten free o free from, così cominciai a studiare e fare esperimenti tra le mura domestiche. Infatti, spesso scontenta e delusa dai prodotti che trovavo in commercio, mi sono posta degli obiettivi cercando di venire
incontro ai miei gusti e questi sono stati raggiunti con il lavoro congiunto mio e di mia madre Carmela. Abbiamo unito forze e conoscenze, e abbiamo raggiunto risultati straordinari. Li abbiamo poi condivisi anche in occasione di corsi presso diverse realtà formative.
Cosa s’intende esattamente per intolleranza?
È l’incapacità dell’apparato gastrointestinale di assorbire e/o metabolizzare alcuni componenti degli alimenti, come il lattosio nel latte e il glutine nelle farine di grano, orzo, farro e segale.
E per allergia?
È una reazione immediata e/o eccessiva del sistema immunitario. Viene classificata come malattia, che si correla alla produzione di anticorpi (immunoglobine E-IgE) nei confronti delle proteine contenute in alcuni alimenti.
“
l’incapacità dell’apparato gastrointestinale di assorbire e/o metabolizzare alcuni componenti degli alimenti, come il lattosio nel latte e il glutine nelle farine di grano, orzo, farro e segale
“ L’intolleranza è
“
L’allergia è una reazione immediata e/o eccessiva del sistema immunitario. Viene classificata come malattia, che si correla alla produzione di anticorpi (immunoglobine E-IgE) nei confronti delle proteine contenute in alcuni alimenti
“
Quali sono le regole fondamentali che devono essere applicate in laboratorio quando s’intraprende questo tipo di produzione, anche dal punto di vista normativo?
La regola fondamentale è quella di evitare la cross contamination, in questo caso riferita alle materie prime. L’opzione migliore per chi si occupa di prodotti sensibili è di avere un laboratorio adibito solo a questo tipo di lavorazioni. La parte legislativa e normativa è molto ampia e complessa e approfondiremo l’argomento nei prossimi articoli.
Quali sono i principali mezzi per esaltare la bontà dei prodotti?
Utilizzare materie prime semplici e cercare di mantenerle tali: ecco il se-
greto per esprimere la bontà e, in questa rubrica, forniremo ricette free from, incominciando già da questo numero.
Come lavori per stilare le ricette?
L’obiettivo è quello di creare un prodotto avendo in mente il risultato che si vuole ottenere. Lavoro sull’insieme delle caratteristiche strutturali e sensoriali, spaziando dal gusto all’odore, dal tipo d’impasto e alle tipologie di cottura e, una volta delineata l’immagine del prodotto, comincio a lavorare nello specifico sugli ingredienti. In questa fase è
Diamantini cacao e arancia senza glutine e senza lattosio
burro delattosato
g 150 saccarosio
g 150 zeste d’arancia
g 15 vaniglia q.b. uova
g 83 farina di riso
g 375 cacao
g 30 baking
g 4,50 sale
g 1,5
Lavorare a crema burro, saccarosio e aromi, aggiungere le uova e poi an che le farine. Far riposare una notte in frigorifero. Formare dei filoncini e abbattere. Togliere dall’abbattitore e tagliare delle fettine. Cottura a 160°C.
NOTA
Il burro delattosato è burro senza lattosio: subisce un trattamento con l’enzima lattasi, che scinde il lattosio in galattosio e glucosio.

al grano saraceno, cioccolato e fiocchi d’avena senza glutine e senza lattosio
fiocchi d’avena
zucchero
farina di grano saraceno
burro delattosato
gocce al cioccolato fondente
granella di nocciole
uova
baking
sale
g 265
g 150
g 180
g 150
g 120
g 50
g 75
g 2
g 0,5
bacca di vaniglia n. ½
Montare burro e zucchero, quindi incorporare sale, farina di grano saraceno, baking, granella, gocce al cioccolato e fiocchi d’avena. Impastare il tutto e far riposare in frigorifero.
Formare delle palline e cuocere a 165°C.

burro delattosato
zucchero
zeste di limone
uova
fecola
farina di mais
farina di riso
nocciole
mandorle
gocce al cioccolato
g 180
g 200
g 20
g 100
g 80
g 80
g 320
g 100
g 100
g 80
vaniglia q.b.
Lavorare a crema burro, zucchero e aromi, quindi aggiungere uovo e poi farine, infine frutta secca e cioccolato.
Far raffermare in frigorifero e versare negli appositi stampi. Cottura 160°C.
Proponiamo la versione piccola della torta, ma si può realizzare in vari formati.
Camilla Capuano e Carmela Moffa Ricette sviluppate per corsi in Hangar78, scuola di Silikomart con sede a Pianiga, Ve

(per 2 persone)
Ingredienti
tofu al naturale g 200
cucchiai di salsa di soia n. 3
porro (la parte bianca) n. 1
carota media n. 1
funghi champignon n. 8
foglie di verza al netto della parte centrale più dura g 200 olio evo q.b.
Per la salsa
cucchiai di burro di arachidi al naturale n. 2
cucchiaini di miso rosso n. 2
cucchiaini di aceto di mele n. 2
cucchiaini di sciroppo d’acero n. 2
Procedimento
Preparare la salsa mescolando insieme tutti gli ingredienti previsti per la preparazione e aggiungendo due o tre cucchiai d’acqua per diluirla.
Tagliare la carota pelata e il porro a rondelle sottili, pulire i funghi togliendo la parte terrosa del gambo e tagliarli a fettine. Scaldare un paio di cucchiai d’olio nel wok e versare il porro e la carota; non appena si saranno leggermente ammorbiditi, unire i funghi e, dopo circa un minuto, la verza mondata e tagliata a listarelle. Fare saltare per un paio di minuti, poi sfumare con due cucchiai di salsa di soia e aggiungere un goccio d’acqua per stufare le verdure fino a renderle morbide,

ma ancora un po’ croccanti. Toglierle dal wok e tenerle in caldo.
Scaldare ancora un cucchiaio d’olio nel wok e unire il tofu a fettine, facendolo dorare da entrambi i lati, quindi sfumare con il cucchiaio rimanente di salsa di soia e spegnere il fuoco.
Disporre sul piatto le verdure con sopra il tofu e la salsa come topping.
Giulia Giunta docente FunnyVeg Academy academy.funnyveg.com
Foto Andrea Tiziano Farinati

Il miso è un alimento fermentato a base di legumi (in genere soia) e cereali. È tipico della tradizione giapponese e macrobiotica, ma diffuso in tutte le cucine asiatiche. Si presenta come una pasta cremosa e densa molto sapida e umami, la cui intensità di sapore cambia in base alle diverse tipologie e al grado di fermentazione (ad esempio, lo shiro miso o miso bianco è il più delicato, mentre l’hatcho miso o miso rosso è più forte e pungente). È usato in genere per insaporire zuppe, salse, brodi e verdure; ha proprietà probiotiche, digestive, antitumorali e rinforza il sistema immunitario, oltre ad essere ricco di proteine e vitamine del gruppo B. Per mantenere intatte le proprietà, si consiglia di non cuocerlo o aggiungerlo a fuoco spento. Visto il suo elevato contenuto di sale, è sconsigliato a chi soffre di ipertensione.


Nelle valli nebbiose e fertili della provincia di Guangxi, nel sud della Cina, cresce un piccolo frutto verde chiamato Luo Han Guo. Secondo la tradizione, furono i monaci buddisti, già nel XIII secolo, a coltivarlo e custodirne le virtù: da allora, il frutto del monaco – Monk Fruit – ha conservato un’aura di preziosità, che oggi incontra la scienza e arriva sul mercato italiano grazie alla partnership esclusiva tra Giusto Faravelli e Huacheng Bio, produttore leader di ingredienti naturali.
In Italia come in Europa, secondo la legislazione vigente, il prodotto commercializzato sottoforma di decotto non è considerato un Novel food; può essere utilizzato in prodotti alimentari ed integratori ed è disponibile sia in forma liquida concentrata, che in polvere. È un dolcificante naturale estratto con acqua direttamente dal frutto della Siraitia grosvenorii. Circa 15-20 volte più dolce dello zucchero, con un apporto calorico ridotto (253 kcal per 100 g), è utilizzato a dosaggi molto più bassi del saccarosio (1-3%), apportando nei prodotti
finiti, a parità di dolcezza, solo il 5% circa delle calorie dello zucchero tradizionale: una soluzione che conserva naturalità e gradevolezza, risultando anti-cariogena e di facile impiego.
Il profilo sensoriale rotondo, privo di retrogusti indesiderati, è il plus del Monk Fruit rispetto ad altri dolcificanti, in particolare quelli intensivi.
In quanto resistente al calore, solubile e versatile, adatto in un ampio intervallo di pH, è indicato in bevande, bustine monodose e soluzioni table-top, ma anche in prodotti da forno, gelati, yogurt, confetture, cioccolato, caramelle e salse. Può essere miscelato con altri edulcoranti naturali come stevia o eritritolo per migliorare il profilo sensoriale.
Come evidenziano le indagini di diversi analisti, il mercato globale del Monk Fruit è in rapida espansione: da 1,5 miliardi di USD nel 2024 a quasi 3,8 miliardi entro il 2033 (CAGR 10,5%), e anche in Italia cresce l’interesse, spinto da trend come salute, sostenibilità e clean label.
Marchio di riferimento per le farine dedicate a preparazioni dolci e salate, Molino Vigevano è stato il primo a sviluppare delle linee specializzate per uso sia professionale che casalingo, con l’obiettivo di migliorare il benessere e semplificare la vita dei consumatori. I prodotti sono concepiti nel rispetto della tradizione molitoria, arricchiti con germe di grano vitale, ovvero il cuore del chicco, ricco di nutrienti essenziali, un ingrediente naturale che apporta benefici nutrizionali grazie al contenuto di calcio, fosforo, magnesio e vitamine, favorendo la maturazione completa dell’impasto, attraverso la presenza di zuccheri semplici biodisponibili all’interno del germe stesso. Nella vasta gamma, la referenza distintiva è Vesuvio, che nasce dall’esigenza di ricreare la pizza napoletana anche nel forno elettrico. Molino Vigevano sceglie, anche in questo caso, il germe di grano ancora vitale, per infondere nei prodotti aroma e gusto inconfondibili, insieme al caratteristico colore dorato. A conferma degli obiettivi raggiunti, nel 2025 Vesuvio è stata una delle referenze elette Prodotto dell’Anno per la categoria Farine e Preparati dalla ricerca Circana, condotta su più di 12.000 consumatori italiani: il 95,8% degli intervistati che ha dichiarato di aver provato il prodotto l’ha trovato “molto soddisfacente”, apprezzando la varietà della gamma di farine, con un plauso per i pack riciclabili, con certificazione Aticelca, realizzati da materie prime gestite in maniera sostenibile da fonte controllata FSC.
L’azienda aromatiera New Flavours, eccellenza dell’aroma biologico e naturale, nasce dalla convinzione che la natura offra tutto ciò che serve per creare aromi autentici, ricchi di proprietà benefiche. Per questo ha ricercato e studiato metodi di estrazione non invasivi e sostenibili per la produzione di aromi naturali.
Uno studio pubblicato in collaborazione con New Flavours su European Food Research and Technology analizza il metodo di estrazione del peperoncino calabrese (Capsicum annuum L.), che


permette di ottenere aromi 100% naturali e biologici, senza l’impiego di solventi chimici né processi che intaccano le proprietà intrinseche delle spezie. Il peperoncino non solo dona piccantezza e colore, ma racchiude preziosi composti bioattivi, capsaicinoidi, polifenoli, carotenoidi e vitamine A e C. L’aroma di New Flavours conserva, oltre alle note aromatiche più caratteristiche, i principi attivi naturalmente presenti. Principi su cui si concentra la ricerca dell’azienda umbra, in collaborazione con diverse università e centri di ricerca. Gli estratti contengono vitamine, antiossidanti e molecole bioattive capaci di arricchire l’esperienza sensoriale.
La sinergia fra tradizione, innovazione e sostenibilità comporta il rispetto della materia prima nella sua integrità da un lato e dall’altro l’investimento in tecnologie e studi che le permettono di esplorarne ogni potenzialità. Attraverso i processi utilizzati New Flavours riesce a preservare e concentrare queste sostanze, trasformandole in un aroma che non è soltanto gusto, ma anche nutrimento, restituendo al consumatore l’essenza autentica della natura, arricchita dal valore aggiunto della ricerca scientifica.
Parliamo di idratazione funzionale e non solo con Vincenzo Morreale, fondatore di Bioinagro
Nata in Sicilia nel 2017, Bioinagro ha saputo distinguersi quale pioniere nella valorizzazione integrale del fico d’India (Opuntia ficus-indica). Con un approccio di economia circolare e una forte vocazione alla ricerca, l’azienda oggi è riconosciuta come uno dei riferimenti principali nella cosiddetta Cactus Economy, con applicazioni che spaziano dal food & beverage alla nutraceutica, dalla cosmesi fino al biotech. Incontriamo quindi il fondatore Vincenzo Morreale, per approfondire storia, filosofia e prospettive future.
Da dove nasce l’idea di Bioinagro?
Tutto è iniziato oltre vent’anni fa con la trasformazione degli scarti di po-

tatura del fico d’India in farine ricche di fibre solubili. È stata una scelta di economia circolare, quasi pionieristica per l’epoca. Da lì ho intuito che i cladodi contenevano preziose acque vegetali, generalmente disperse nei processi di disidratazione. Oggi, grazie ai nostri processi proprietari, riusciamo a preservarle e a trasformarle in un ingrediente funzionale di altissimo valore.
Qual è la filosofia che vi guida? È racchiusa nel nostro motto: “Cactus for People. For Planet”. Crediamo che il cactus mediterraneo possa diventare un simbolo universale di resilienza. Lavoriamo per portare benefici concreti al consumatore – in termini di salute e benessere – e al tempo stesso per restituire valore all’ambiente e ai territori agricoli.
Quali sono le principali linee di prodotto?
La nostra offerta è molto diversificata: abbiamo le acque di cactus, perfette come base per bevande funzionali; le farine funzionali ricche di fibre e mucillagini; gli estratti bioattivi concentrati per nutraceutica e cosmesi, utilizzati soprattutto nella skincare. A questo si aggiungono le frazioni innovative, come mucillagini isolate e peptidi bioattivi, ancora in fase di ricerca e sviluppo. Queste sono le linee consumer che abbiamo sviluppato a partire dalla nostra disponibilità di materia prima e di know-how, che si è accumulato nel tempo anche grazie alla disponibilità di numerosi asset come le piantagioni di fico d’India (50 ettari in Sicilia, in coltivazione bio), i laboratori di prima estrazione a pochi chilometri dai centri di raccolta, i laboratori di confezionamento primario e secondario – in Abruzzo – per la linea bicchieri e in Lombardia per la linea sleveragaggio e confezionamento in

“I cladodi del fico d’India contengono preziose acque vegetali, generalmente disperse nei processi di disidratazione
“bottiglia. Questi asset possono essere forniti e licenziati anche in private label e come semilavorati ai player internazionali della nutrizione funzionale. Ci sono molteplici proposte in valutazione.
Avete già portato sul mercato dei brand consumer?
Sì, ci sono diversi esempi che raccontano bene il potenziale dei nostri estratti. Juipal, la nostra Acqua di Cactus funzionale; DolceZero, bevanda sugar free definita “la tua buona idratazione”; AquaPlanta, botaniche zero alcool da pasto, e Cactus, bevande ipocaloriche con succhi premium mediterranei, che saranno presentate nei prossimi eventi fieristici internazionali, e infine SweetGold/FreshPal, che valorizzano il frutto fresco e i cladodi per consumo diretto.

La sostenibilità è parte integrante del vostro modello: come la interpretate concretamente?
Per noi la sostenibilità non è uno slogan ma una pratica quotidiana. Recuperiamo il 100% delle frazioni della pianta, riduciamo del 70% l’impronta idrica rispetto ad altre colture da beverage e stimiamo una cattura di circa 5 tonnellate di CO₂ per ettaro all’anno. Inoltre, lavoriamo con filiere certificate e packaging riciclabili o compostabili, mentre la tracciabilità è garantita da sistemi blockchain.
Bioinagro è protagonista di diverse fiere e riconoscimenti. Può raccontarci qualcosa a proposito?
Quali prospettive vede per Bioinagro nei prossimi anni?
Vogliamo rafforzare il nostro ruolo di hub internazionale della Cactus Economy. Entro il 2030 puntiamo a raggiungere la piena circolarità della biomassa, ad espanderci in Nord America e Medio Oriente e ad entrare nei mercati asiatici del wellness. Le linee prioritarie sono nutraceutica avanzata, biotech per materiali green e cosmesi premium. Vogliamo
“ “ In Sicilia disponiamo di 50 ettari di piantagioni di fico d’India e la coltivazione è bio
Negli ultimi anni abbiamo partecipato a fiere di riferimento come Sana, Marca, Biofach, Beer & food. Proprio a Rimini, al Beer & Food Attraction 2025, la nostra linea DolceZero ha vinto il premio internazionale Lorenzo Cagnoni Award, classificandosi al primo posto nella categoria soft drink no/low alcohol. È stato un riconoscimento importante, che ha confermato la validità del nostro lavoro e l’interesse del mercato verso l’idratazione funzionale.
Qual è oggi la vostra presenza internazionale?
L’Italia è il nostro hub produttivo, ma abbiamo già avviato espansioni in Germania, Francia e Scandinavia, mercati molto recettivi verso prodotti sostenibili e funzionali. Stiamo inoltre consolidando i rapporti in Nord America, dove la functional hydration e gli integratori plant-based hanno tassi di crescita elevati. Il Medio Oriente è un’altra area strategica, per via della forte domanda di bevande premium in contesti climatici aridi. Infine, guardiamo con interesse all’Asia, in particolare ai segmenti wellness e cosmesi naturale, che stanno crescendo rapidamente.

che Bioinagro diventi un benchmark globale per l’innovazione sostenibile legata al cactus mediterraneo.
La visione di Morreale e di Bioinagro è quindi precisa: trasformare il fico d’India in una risorsa globale, capace di generare innovazione, benessere e sostenibilità. Dai riconoscimenti internazionali alla presenza consolidata nelle fiere di settore, fino ai piani di espansione nei mercati chiave, la volontà è dimostrare che il cactus non è solo una pianta resiliente, ma anche un driver di sviluppo per il futuro del food, della nutraceutica e della cosmesi. Un progetto che parte dalla Sicilia per parlare al mondo intero.
www.bioinagro.it
Uno stile di vita equilibrato con la prevenzione mantenendosi attivi e alimentarsi in modo sano; è a quest’ultimo punto che gli italiani prestano più attenzione in fatto di salute, lo dice una ricerca dell’Osservatorio Sanità di UniSalute e Nomisma. Quasi sei su dieci seguono un’alimentazione sana e bilanciata; due su tre consumano frequentemente frutta e verdura. Il 66% evita snack salati, il 47% limita anche i dolci. Resta più difficile rinunciare a
pasta, pane e riso, che figurano con regolarità nelle abitudini dell’86% degli intervistati.
Rispetto al 2023 ci alleniamo di più, tuttavia ancora più di un italiano su cinque ammette di essere sedentario, mentre il 42% pratica sport in modo occasionale contro il il 37% degli uomini che lo fa regolarmente, mentre le donne si allenano meno.
Vi sono altre attenzioni rivolte al benessere: c’è chi sceglie di adottare uno stile di vita equilibrato tra lavoro,

tempo libero e cura di sé, chi evita fumo o alcool (40%) e chi punta a migliorare la qualità del proprio riposo.
Secondo UniSalute la maggioranza del campione dichiara di essere in uno stato di salute fisico almeno buono, solo uno su tre (34%) definisce la propria salute come molto buona o eccellente; oltre uno su cinque (21%) giudica il proprio stato psicologico come mediocre o pessimo. Colpa dello stress per quasi metà del campione.
FIBO Arabia si tiene dall’1 al 3 ottobre 2025 al Front Exhibition & Conference Center di Riyadh, offrendo ad aziende locali e internazionali una piattaforma per incontrare buyer, partner, distributori e consumatori appassionati di salute e benessere, considerando che il settore sportivo saudita ha registrato una crescita significativa: nel 2023 il valore complessivo ha superato i 7,1 miliardi di dollari, rispetto ai 6,3 miliardi del 2022, grazie alle iniziative governative come Vision 2030 e a una crescente attenzione della popolazione alla salute e al fitness. In linea con Vision 2030, il Governo Saudita punta a far crescere la popolazione fisicamente attiva dal 13 al 40% entro il 2030 e promuove
iniziative come il programma “Quality of Life”, che incoraggia la partecipazione sportiva e l’eccellenza in alcuni sport professionistici.
FIBO Arabia mira a consolidare il settore del fitness e promuovere una società sana, offrendo aggiornamenti continui su innovazioni, investimenti e tendenze per uno stile di vita attivo. In tre giorni, l’evento riunisce i protagonisti globali dei settori salute, fitness e benessere, con segmenti dedicati ad attrezzature fitness, ospitalità, nutrizione sportiva, tecnologie per il fitness, attrezzature mediche sportive, allenamento funzionale e benessere.
Grazie a esperienze dal vivo, è un appuntamento di riferimento per chiunque voglia vivere e investire nel mondo della salute e del fitness in Medio Oriente.
L’evento faro degli ingredienti alimentari ritorna a Parigi, dal 2 al 4 dicembre 2025, presso il Paris Expo Porte de Versailles, per celebrare la 30ª edizione insieme alla community globale del food & beverage, e per vivere l’energia dei nuovi sviluppi, delle connessioni vantaggiose e delle collaborazioni foriere d’ispirazione, grazie alla partecipazione di oltre 1.550 espositori distribuiti in quattro aree tematiche. L’edizione del 2025 di Fi Europe, caratterizzata dal programma più ricco di sempre, ospiterà infatti i principali fornitori mondiali, tra cui ADM, Beneo, Nexira, Robertet e FrieslandCampina Ingredients, accanto a startup all’avanguardia.
La posizione centrale della sede espositiva offre un’ottima accessibilità per gli oltre 24.000 partecipanti attesi in città da oltre 135 nazioni, con un’area ampliata che affronta le attuali priorità mediante quattro aree distinte, per un ampio assortimento di ingredienti funzionali e ad alto valore aggiunto, innovazioni nutrizionali supportate dalla scienza ed emergenti, oltre a 25 padiglioni internazionali che esporranno soluzioni a livello regionale. Da segnalare anche la nuova zona Ready-to-Market destinata ai prodotti finiti, che mostra in modo tangibile come gli ingredienti si traducano in innovazioni pronte al consumo.
Dopo il successo registrato al debutto nel 2024, fa il suo ritorno anche il Petfood Suppliers Hub, dedicato ai fornitori di cibo per animali, in cui saranno presentati ingredienti, tecnologie e soluzioni per l’imballaggio e la lavorazione, nonché contenuti selezionati relativi alle tendenze, alle normative e alla sicurezza.
Infine, la zona Food Technology & Solutions offrirà l’accesso a tecnologie in grado di ottimizzare l’efficienza, semplificare le operazioni e proteggere le catene di approvvigionamento.
Completano l’offerta il padiglione dedicato alle startup e la Startup Challenge, durante la quale i finalisti presenteranno le loro idee rivoluzionarie.
Il Conference and Innovation Hub di Fi Europe fornirà analisi e approfondimenti, mentre gli Innovation Tour giornalieri guideranno i partecipanti alla scoperta dei prodotti e fornitori in linea con le tendenze di mercato. Nella New Product Zone, invece, sarà possibile esplorare le più recenti innovazioni di prodotto presentate dai leader. Il Future of Nutrition Summit si trasforma in un’esperienza intima di “lunch & learn”, in cui interagire direttamente con i pionieri del settore e instaurare rapporti sulla base delle informazioni condivise. E le opportunità di networking proseguono oltre le sessioni ufficiali, grazie a iniziative mirate, tra cui la Women’s Networking Breakfast e a un programma dedicato al networking nell’ambito del pet food. Il culmine della celebrazione sarà il Fi Europe Celebration and Awards Party, in cui saranno premiate le eccellenze per innovazione, sostenibilità e tecnologia alimentare, in una serata di riconoscimenti e networking rivolta alle partnership che guideranno le prossime innovazioni alimentari. Con oltre un milione di partecipanti nel corso della sua storia e la facilitazione di transazioni commerciali dal valore di miliardi di euro, Fi Europe si conferma come la piattaforma di riferimento per l’industria globale degli ingredienti alimentari; un hub fidato in cui l’innovazione accelera e il futuro sostenibile dell’alimentazione si costruisce concretamente.
Probios Group, player di riferimento nazionale nel settore dell’alimentazione salutistica, biologica e free-from, ha acquisito la quota di maggioranza del capitale sociale di BMS, azienda umbra specializzata nell’acquisto, nella trasformazione e nella commercializzazione di prodotti agroalimentari biologici, salutistici e free-from, in particolare, cereali per la colazione, semi, legumi, farine gluten free e frutta secca. Il Gruppo Probios che già deteneva il 30% del capitale sociale di BMS, incrementa la propria partecipazione portandola al 60% e segna un nuovo passaggio chiave nella strategia di integrazione verticale del Gruppo.
L’operazione estende il presidio lungo l’intera filiera produttiva e consolida la capacità di offerta di Probios Group sul mercato europeo ed internazionale.

È in uno degli angoli più vivaci del quartiere di Poblenou e si chiama Magma Bakery Lab, spazio dove pane, arte ed etica condividono la tavola. È il frutto dell’ingegno di Sara Pennacchio e Toni Rodriguez, un’italiana e un catalano, che hanno fatto della pasticceria vegana una forma di espressione. Dopo aver formato per anni numerosi allievi presso la loro Wild Slice Academy, sempre a Barcellona, sostenendo che l’alta pasticceria non ha bisogno di ingredienti di origine animale per emozionare, hanno aperto il loro laboratorio, in cui la parola vegano non compare: fra le creazioni che campeggiano in vetrina, dolci che fondono tradizione e giocosità, come rotolini alla cannella, croissant alle noci pecan, danesi alle mele o il Dubai Pain Suisse ai pistacchi. D.B. instagram.com/magma.bakerylab

Dopo tanti viaggi, esperienze e crescita, il pasticciere italovenezuelano
David Patino oggi si dedica alla ricerca e sviluppo, in qualità di direttore creativo di Mason Chocolates nell’isola indonesiana di Bali. Un impegno che

ha portato alla produzione del primo “cioccolato verde” con foglie dell’albero di cacao. “Non si può tecnicamente chiamare cioccolato, ma è una creazione nuova – spiega Patino -. Tutto nasce dall’idea del tè Matcha e da una mia sfida: invece di usare foglie di tè, perché non provare a valorizzare le foglie del cacao? Così ho iniziato una lunga ricerca sul campo: ho studiato come si lavora il Matcha, ho testato più varietà di foglie di cacao, ho sperimentato metodi per estrarre il colore verde naturale e, soprattutto, per ‘capire’ il
sapore delle foglie”. Il delicato processo messo a punto parte dalla selezione manuale delle foglie più verdi, più giovani, che si lavorano con cura per mantenere bassa la temperatura per non alterare gusto e colore. Il risultato è una green bar intensa, dal gusto erbaceo ma morbido, con note selvatiche. Un gusto nuovo, originale, sostenibile. masonchocolates.com
La trasformazione in farina aumenta la versatilità di legumi e frutta secca a guscio, consentendone l’utilizzo in svariate applicazioni. Oltre a essere prive di colesterolo e glutine e ricche di fibre, queste farine forniscono proteine alternative e alti livelli di nutrienti e composti bioattivi, ma presentano dei limiti: irrancidiscono facilmente (specie quelle di frutta secca), producono impasti con scarse proprietà viscoelastiche e possono contenere composti antinutrizionali che riducono la digeribilità delle proteine e l’assorbimento dei nutrienti. Per contrastare questi limiti vengono sottoposte a diversi trattamenti, quali sgrassatura, decorticazione, tostatura, cottura a estrusione. Un lavoro di ricerca, a cui ha partecipato anche l’Università degli Studi di Milano, ha analizzato 35 farine commerciali (19 di legumi e 16 di frutta secca a guscio) valutandone le caratteristiche compositive e le proprietà tecnologiche, per capire quanto la specie botanica, la provenienza geografica e il trattamento influiscano. Tra i risultati, si è visto che con il trattamento termico le proprietà emulsionanti e schiumogene diminuiscono nelle farine di castagne, mentre aumentano in quelle di nocciole. Le proprietà

schiumogene, inoltre, risentono della specie botanica nel caso dei legumi, con la farina di lupino potenzialmente più adatta per prodotti aerati. L’origine geografica, invece, influenza l’assorbimento di acqua nelle farine di frutta secca a guscio, mentre un contenuto di grassi più elevato nella frutta secca a guscio è correlato con le proprietà emulsionanti, suggerendo che farine non sgrassate sono preferibili per creme e condimenti
vegani. Le correlazioni osservate forniscono informazioni utili a guidare la scelta delle farine più adatte per formulazioni alimentari “su misura”, favorendo la diversificazione dei prodotti a base vegetale nell’industria alimentare. R.C. (Rif.: Cappa C., Legume and nut flours from the Mediterranean area: proximate compositions, techno-functionalities, and spectroscopy patterns as a function of species, origin, and treatment, LWT - Food Science and Technology 223 (2025) 117770)
Si chiama Coutume ed è uno dei più importanti attori dello specialty coffee a Parigi che, al secondo piano di Galeries Lafayette, sotto la celebre cupola, pro pone i cru di caffè di Colombia, Etiopia e Guatemala, con 40 posti a sedere. Qui, il pasticciere François Daubinet presenta Orchidée a base di vaniglia di Tahiti e caffè bianco, e Origine, che rende omaggio all’incontro di cacao, caffè e vaniglia. D.B. coutumecafe.com


Giusto Faravelli - www.faravelli.it ......................................
CHIRIOTTI EDITORI srl
Viale Rimembranza, 60 10064 Pinerolo TO Per ordini immediati: Tel. 0121 378147 abbonamenti@chiriottieditori.it shop.chiriottieditori.it Per sottoscrivere un abbonamento annuo a:
DATI PER LA SPEDIZIONE





o € 60,00 9 fascicoli o Digitale € 34,99

o € 20,00 4 fascicoli

o € 20,00 4 fascicoli
nome ditta/ente via città prov. cap tel. p.iva /cf
e - mail
Sottoscrivendo l’abbonamento si autorizza il trattamento dei dati ai sensi del Regolamento UE 679/2016 recante “Regolamento generale sulla protezione dei dati”. Si esprime quindi il consenso al trattamento ed alla comunicazione degli stessi. Chiriotti Editori srl, in qualità di Titolare del trattamento, è tenuta a fornirti informazioni in merito all’utilizzo dei tuoi dati personali.
❍ Bonifico bancario IBAN IT05X0306930750100000078152 (specificare quale abbonamento nella causale)
❍ Contrassegno (solo per l’Italia)
❍ C.C. postale n. 10846103 (da utilizzare solo per la versione cartacea) Scegliamo di pagare l’importo con:




CHIRIOTTI EDITORI SRL




Viale Rimembranza, 60 - 10064 PINEROLO (TO) - Tel. 0121 378147 - abbonamenti@chiriottieditori.it

shop.chiriottieditori.it



#FARAcustomizedfunctionalsolutions
I sistemi funzionali FARA® ti offrono la soluzione ideale per ottenere la ricetta perfetta, proprio quella che stai cercando: stabile, bilanciata, personalizzata, sostenibile. La soluzione “smart” che rende ogni cliente soddisfatto e felice.

“Accompagniamo con competenza globale e sensibilità locale i nostri partner verso scelte innovative, per formulare il futuro con ingredienti e soluzioni affidabili e sostenibili”.



